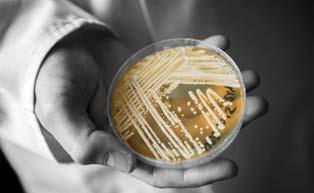

Issue 71 / 202 - JUL/AUG 2023

Those who observe the development of medical tourism in the Arab region realize how much it has evolved and changed, and has reached very advanced positions, both in terms of the constantly increasing numbers and the financial returns it achieves for the economies of these countries, specifically in the investment in the healthcare sector. Not only that, but Arab countries that were not previously at the forefront in terms of this aspect of the healthcare industry have now become competitors to the leading and most established countries in medical tourism worldwide.
In the recent past, medical tourism was limited to specific Arab countries, including Jordan, Egypt, Lebanon, and Tunisia. What encouraged the emergence of these countries was their possession of several attractions for medical treatment. These attractions include natural resources, climate, and historical sites suitable for natural therapy, as well as the medical expertise and skills of their healthcare teams.
For example, Jordan is rich in hot mineral water, mud therapy, herbs, and essential oils, in addition to the wide expertise of its doctors and the high level of its hospitals. Jordan is considered one of the leading countries in the field of recovery and medical tourism. In Egypt, there are many areas that are considered primary destinations for medical tourism, such as Bir Sigam, known for its hot sulfuric waters that help with relaxation and recovery, as well as Siwa, Safaga, and Helwan Springs. The same applies to Tunisia and Lebanon.
What is remarkable in this field is the strong entry of Gulf countries into the field of medical tourism, where they now attract millions of medical seekers annually. This number is increased by the high percentage of tourists in general visiting these countries, especially Saudi Arabia, Qatar, and the United Arab Emirates, where the number of international arrivals exceeded 12 million tourists in the first half of 2023. The high development plans and expenditure on medical institutions have proven their effectiveness, placing these countries among the globally advanced nations in this regard.
Publisher
Publisher Arab Health Media Communication
President Simon Chammas schammas@tahmag.com
Executive Vice President Mirna Khairallah mirna@tahmag.com
Senior Editor Elham Najem editorial@tahmag.com
Content Executive Jessica Achkar editorial@tahmag.com
Editors
Aline Debes, Mark Steven, Don Karn, Andrew Weichert, Colette Semaan, Abbas Moussa
Content Marketing Manager Jessie Chlela jessie@tahmag.com
Creative Director Rania Khalil rania@tahmag.com
Business Development Manager Wadih Chammas wadih@tahmag.com
IT Manager Elie Yammine elie@tahmag.com
Photographer Hanna Nehme
Advertising advertising@thearabhospital.com
OFFICES
IHMC, Cyprus +357 96 158661
Dubai +971 50 2971007
Printing
Distribution
KSA - UAE - OMAN - TURKEY LEBANON - JORDAN - KUWAIT BAHRAIN - QATAR - EGYPT
All images from shutterstock© unless provided by clients .
All rights reserved by the HOSPITALS magazine. No part of this publication can be reproduced in any form without prior permission in writting from the publisher.

3
MEDICAL TOURISM IS EXPANDING IN THE ARAB WORLD. THE GULF COUNTRIES ARE ENTERING STRONGLY AND STEADILY.
CONTENTS




40 Candida Auris
Drug-resistant fungal infection

46 Mr. Nasib Nasr

"The hospital network will expand this year and in the years to come."
72
UChicago Medicine
Patients with diabetes insulin-free for years after islet transplantation


48
INTERVIEWS
28 Dr. Mahrukh Rizvi, Assistant Professor of Medicine, Weill Cornell Medicine-Qatar
46 Mr. Nasib Nasr, General Director of Hôtel-Dieu de France
48 Dr. Ziad Zakaria, MD, FACS, Endocrine Surgery at Clemenceau Medical Center - Beirut


62 Dr. Abdulaziz Al Kuwari, CEO of Aspetar Hospital and a Specialist Consultant in Orthopedic and Spinal Surgery at Al-Ahli Hospital

MEDICAL INSTITUTIONS
64 Acibadem International: Comprehensive Extremity Reconstructions in Orthopedic Cancers
72 UChicago Medicine: Patients with diabetes insulin-free for years after islet transplantation
74 Acibadem International: From Despair to Joy for New Mother at Acıbadem Türkiye
76 Marble Medical Center: Achieve a Beautiful Smile with Orthodontics Treatment at Marble Plus Medical Center
84 Achieve a Beautiful Smile with Orthodontics Treatment
62
74
at Marble Plus Medical Center
90 Al-Ahli Hospital saved a 70-year-old female patient from death

ARTICLES
50 Sustainability & Healthcare: A Choice and an Urgent Necessity in Medication Management.
58 Healing Hearts and Empowering Minds: Mental Wellness and Rehabilitation Centers in Alleviating the Global Mental Disease Burden
70 AI, Art & Neuroscience



78 Unearthing the Impact of COVID-19 on Children and Youth’s Mental Health
FEATURES
42 Candida Auris
68 Electronic Health Records

80 What are the principles of accreditation in hospitals?
86 Remarkable Saudi Success In Crowd Medicine
93 Medical Laboratory Accreditation Certificates
CMC Beirut
Interview with Dr. Ziad Zakaria
Acibadem International From Despair to Joy for New Mother
50 Becton Dickinson
Sustainability & Healthcare
Al-Ahli Hospital
Interview with Dr. Abdulaziz Al Kuwari
DEDALUS COMMAND CENTRE

JUST ONE OF OUR 200+ PRODUCTS
A CENTRALISED HEALTHCARE OPERATIONS CONTROL CENTRE IN WHICH REAL-TIME PREDICTIVE ANALYTICS ARE ACCUMULATED FROM VARIOUS DATA SOURCES, TO MANAGE LOGISTICS, VISIBILITY AND COORDINATION WITHIN THE HEALTHCARE ECOSYSTEM
Real-time insights into organizational performance



Improved communication and real-time alerts


Optimised staffing and expedited access to patient care
Improved patient flow with real-time data and reporting
Prospective analytics powered by AI , ML and Digital Twin
LIFE FLOWS THROUGH OUR SOLUTIONS www.dedalus.com/mea
Dubai doctors give eight-year-old full control over her bladder for first time

Ceban is an eight-year-old from Moldova in Eastern Europe. The Dubai-based girl was born with a spinal defect and underwent a surgery as a newborn. She also had associated bladder and bowel problems. Doctors in Italy told her parents she would have to live with a catheter all her life. They even made a provision for her bladder to be catheterized from her belly.
The little girl, who grappled with the physiological and psychological effects of her condition, could not lead a normal life. She came down with frequent urinary tract infections and was put on antibiotics regularly. Life was extremely difficult for Ceban until her parents brought her to Prof. Dr. Haluk Kulaksizoglu, a leading expert in neuro-urology at Neurospinal Hospital Dubai. The eight-year-old was diagnosed with Spina Bifida, a congenital condition affecting the spinal cord.
Thankfully, Dr. Haluk Kulaksizoglu was adequately qualified and equipped to treat her with a breakthrough approach. The innovative treatment, which utilized sacral nerve stimulation, was being applied for the first time on an eightyear-old patient in the UAE. But he was confident it would make a difference . “The procedure had immediate results, enabling the patient to empty the bladder by herself without the need of a catheter for the first time in her life. Sacral nerve stimulation represents a groundbreaking approach to managing Spina Bifida. By targeting the neural pathways responsible for bladder and bowel control, we can restore functionality and improve the lives of patients who have long struggled with these challenges,” said the doctor.
He still recalls the first time Ceban entered the consultation room with her mother. She was scared and did not know what to expect. She understood English and wanted to get rid of the tube and the foul smell associated with it. After thorough investigations, she was told that the suprapubic tube could be first removed after which her bladder would be closed. “Once the initial procedure was done, we had to wait for
the bladder to heal and for the already resistant bacteria to be eradicated. Everything that would follow the first procedure was explained and all she wanted to know was if she could swim when the tube was closed. There was a longing in her eyes to lead a normal life,” said the doctor.
Her recovery over the next month took longer than usual due to pre-existing infections but she eventually came through. As the youngest patient to receive an ‘Interstim II sacral nerve stimulator’, she had to undergo a trial first.
An electric conduction study of the nerves, called EMG, showed promising data and she was scheduled for the second stage where a test stimulator would be placed and results evaluated for a permanent stimulator placement. For the family, it was like battling with the unknown and the little girl was ready to go through anything the doctors decided for her if she could just swim, do gymnastics and lead a normal life.
When Dr. Kulaksizoglu went to her room on the day of the surgery, Ceban hugged him with a bright smile. The surgery went off smoothly and despite some of the challenges she faced, she could do without the use of a catheter in due course. Her mother was overwhelmed and in tears as she did not expect such quick results. Her daughter was discharged with the external testing device. Five days later, she came running to Dr. Kulaksizoglu and gave him another big hug. She was ready for the second procedure which also went off well. Ceban had just received a second lease of life.
SPINA BIFIDA IS A CONGENITAL CONDITION AFFECTING THE SPINAL CORD AND POSES SIGNIFICANT CHALLENGES FOR PATIENTS AND THEIR FAMILIES. IT OCCURS WHEN THE SPINAL CORD DOES NOT DEVELOP PROPERLY DURING FOETAL DEVELOPMENT. THIS CONDITION CAN LEAD TO VARIOUS IMPAIRMENTS, INCLUDING DIFFICULTIES WITH MOBILITY, BOWEL AND BLADDER DYSFUNCTION, AND LOSS OF SENSATION.
JULY.AUG 2023 8
NEWS

AGDA and DIHAD Sustainable Humanitarian Organisation sign a MoU to collaborate on humanitarian programs and initiatives
Anwar Gargash Diplomatic Academy (AGDA) and DIHAD Sustainable Humanitarian Organisation, have signed a Memorandum of Understanding (MoU) to collaborate on educational, humanitarian training programs and initiatives.
The signing ceremony took place at AGDA in Abu Dhabi, where the MoU was signed by His Excellency Nickolay Mladenov, Director General of AGDA, and His Excellency Amb. Dr. Abdulsalam Al Madani, Roving Ambassador for the Parliamentary Assembly of the Mediterranean for the GCC, Chairman of DIHAD Sustainable Humanitarian Organisation, in the presence of leadership members on both sides.
The partnership between AGDA and DIHAD Sustainable Humanitarian Organisation aims to create a space for actively exchanging crucial knowledge and expertise, providing a path to improving the technical and intellectual skills of those involved. This collaboration will focus on the intersection of diplomacy with humanitarian action and discuss the information needed to be successful and impactful in this field of work.
H.E. Nickolay Mladenov, Director General of AGDA, said, “AGDA is excited to partner with DIHAD Sustainable Humanitarian Organisation and collaborate on work related to the global humanitarian challenges. Where we can expand our impact and make a difference in humanitarian diplomacy, this partnership fosters inno-

vation in humanitarian work and exchanging knowledge and experiences with DIHAD. This is a testament to the work AGDA is doing concerning education in the humanitarian space. We launched the Master of Arts (MA) program in Humanitarian Action and Development in 2021, giving those interested and willing to pursue a career in development work an opportunity to learn from experts in this field.”
For his part, H.E. Amb. Dr. Abdulsalam Al Madani, Roving Ambassador for the Parliamentary Assembly of the Mediterranean for the GCC, Chairman of DIHAD Sustainable Humanitarian Organisation, said: "Through this agreement, we aspire to realize the objectives of global humanitarian diplomacy, which has recently started to strengthen its active global role through organisations as well as individuals, to foster cooperation between vulnerable groups, decision-makers, and influencers, and to promote access to resources that can be used to help those in need and strengthen the role of humanitarians worldwide.”
H.E. Amb. Dr. Abdulsalam Al Madani added: "Through the various events, programs, and activities held under DIHAD Sustainable Humanitarian Organisation, we are striving to realize the UAE’s vision concerning long-term development work, which coincides with the announcement of 2023 as being the “Year of Sustainability.” That is why our agenda for this year is focused on sustainability.”
THE PARTNERSHIP BETWEEN AGDA AND DIHAD SUSTAINABLE HUMANITARIAN ORGANISATION AIMS TO CREATE A SPACE FOR ACTIVELY EXCHANGING CRUCIAL KNOWLEDGE AND EXPERTISE, PROVIDING A PATH TO IMPROVING THE TECHNICAL AND INTELLECTUAL SKILLS OF THOSE INVOLVED.
NEWS JULY.AUG 2023 10
For Continous, Individualized Ventilation Care MULTICARE X
This novel method is enabled by combining bed-framed lateralization and continuous visualization of pulmonary ventilation using a non-invasive, radiation-free electrical impedance tomography (EIT) monitor. The Multicare X bed by LINET has expanded the existing options for lateral positioning with the programmed positioning cycle.


Bed-framed lateral rotation by Multicare X bed is available at the maximal angle of 30° left and 30° right
Go to our new website and discover the Multicare X bed
@LINETMEA @LINETMEA
@LINET 23_04_Inzerce Hospitals_MulticareX_220x280_ver04-PRINT.indd 1
Don’t Rely on SPF Makeup or Umbrellas for Protection from the Sun’s Harmful Rays, Says Expert from Cleveland Clinic
Products such as makeup with built-in sunscreen and umbrellas may not deliver the level of protection needed to guard against the sun’s damaging rays and individuals are advised to follow a more comprehensive approach, says an expert from global health system Cleveland Clinic.
“Individuals tend to overestimate the amount of sun protection they are getting from sunscreen-infused makeup products and umbrellas, says dermatologist Amy Kassouf, MD. “In reality, the shade of an umbrella is far less effective than a sunscreen with a high sun protection factor (SPF), while SPF in makeup probably isn’t enough to limit the harmful effects of the sun’s skin-burning ultraviolet (UV) rays.”

With regard to umbrellas, Dr. Kassouf says that while any shade is better than no shade, research into beach umbrellas found 78% of users ended up with sunburn after three and a half hours on the beach. For comparison sake, 25% of those using an SPF 100 sunscreen got sunburned in the same timeframe.
In the case of makeup containing sunscreen, Dr. Kassouf points out that skin care companies slather on an extra thick layer of a product when testing for SPF. “In the real world, individuals do not wear such thick layers of makeup, so you’re more than likely not getting the full protection listed on the label,” she says.
This same dynamic takes place with sunscreen, Dr. Kassouf adds, so an effective strategy can be to double up. “Apply sunscreen with at least SPF 30 and makeup with SPF 30. Together, they’ll add up to the protection you need,” she says.
If a person is using SPF makeup for the convenience of applying fewer products, Dr. Kassouf suggests trying a mineral-based tinted sunblock instead, which she says is one of the best new products for protection against the sun.
“There is some iron oxide added to the sunblock base of zinc and titanium to give it a tan color,” she explains. “This way, you get the
broadest spectrum sun protection in a product that can even your skin tone, as well — and it is just one product to reapply.”
5 tips for applying sunscreen
“It is well known that sun exposure is the top cause of skin cancer, including potentially deadly melanoma,” says Dr. Kassouf. “Sunlight also ages your skin by damaging skin cells, leading to fine lines, wrinkles and discoloration. The primary defense against this damage is to use and regularly reapply a high-SPF factor.”
According to Dr. Kassouf, there are five ways to maximize sunscreen’s efficacy:
1. Choose broad-spectrum sunscreen products, which protect against both UVA and UVB rays, the two types of sun rays that cause harm.
2. Pick sunscreen products with an SPF of at least 30, but preferably higher for a little extra protection, especially if you’re going to be outside for any extended period.
3. Use sunscreen heavily. The most common mistake people make when applying sunscreen is not using enough, says Dr. Kassouf. It should be reapplied about every two hours or more frequently if a person is swimming, sweating or otherwise weakening the previous protective layer.
4. Don’t forget to apply to the neck, arms and any other skin exposed to the sun, not just the face.
5. Pay attention to the expiration date as sunscreen does not last forever and protection will weaken over time.
“People have many options when it comes to protecting their skin from sun damage, including SPF makeup, umbrellas, sunglasses and special sun-protective clothing,” concludes Dr. Kassouf. “They don’t have to pick just one - if they use them all, in fact, they can help protect themselves better.”
IF A PERSON IS USING SPF MAKEUP FOR THE CONVENIENCE OF APPLYING FEWER PRODUCTS, DR. KASSOUF SUGGESTS TRYING A MINERALBASED TINTED SUNBLOCK INSTEAD, WHICH SHE SAYS IS ONE OF THE BEST NEW PRODUCTS FOR PROTECTION AGAINST THE SUN.
ARTICLES JULY.AUG 2023 12
Dr. Amy Kassouf
TURN TO THE ESSENCE OF CARE
With NEW Essenza 300 Hospital Bed Series

Lateral tilt reduces physical strains on the caregiver by 67%
Shorten the length of stay by 1.5 days with the mobilization program.
Bespoken design is an additional bonus.
Low height up to 28 cm helps to reduce patients’ falls.
Smart care solutions help caregivers to be more efficient
@LINETMEA @LINETMEA
@LINET 23_04_Inzerce Hospitals_Essenza_220x280_ver03-PRINT.indd 1
Go to our new website and discover the new Essenza
Thumbay Labs and myAlfred Collaborate to Expand Accessibility of Comprehensive Diagnostic Solutions for InsuranceMarket.ae clients
Thumbay Labs, UAE’s leading healthcare diagnostics provider, has partnered with myAlfred, the UAE’s leading money saving app to provide the customers of InsuranceMarket.ae, the largest insurance platform of the UAE, to expand the reach of their diagnostic services. This collaboration further aims to ensure that individuals in Dubai and the UAE have enhanced access to the most comprehensive health insurance options available in the market.
Under the MoU, Thumbay Labs and myAlfred will work together to expand the availability and reach of diagnostic services to policyholders of InsuranceMarket.ae The tie-up will facilitate seamless access to high-quality diagnostic testing, ensuring individuals can conveniently and efficiently address their healthcare needs. Furthermore, this collaboration will enable InsuranceMarket.ae to offer enhanced healthcare solutions to its customers through myAlfred. Thumbay Labs will provide valuable insights and expertise in healthcare diagnostics, empowering InsuranceMarket.ae to assist individuals in making informed decisions about their health insurance coverage.
"We are excited about our partnership with myAlfred & InsuranceMarket.ae," said Mr. Akbar Moideen Thumbay, Vice President of the Healthcare Division at Thumbay Group. "This collaboration aligns with our commitment to providing comprehensive healthcare solutions to the community, including diagnostic services. By partnering with InsuranceMarket.ae, we can assist individuals in making informed decisions about their diagnostic needs and ensure they have access to the best coverage options available. Together, we aim to enhance the availability and affordability of diagnostic services, empowering individuals in Dubai and the UAE to prioritize their health and well-being."
Through this partnership, Thumbay Labs and InsuranceMarket.ae aim to streamline the

process of obtaining health insurance while prioritizing the importance of diagnostic services. By leveraging their respective strengths and resources, the two organizations strive to create a more integrated and accessible healthcare ecosystem in Dubai and the UAE, ultimately benefiting the community at large.
Meanwhile, Mr. Avinash Babur, Founder & CEO, InsuranceMarket.ae, stated: "We're thrilled to announce this exciting partnership with Thumbay Labs and myAlfred- two leading players in their respective sectors. This collaboration epitomizes our commitment to providing exceptional service and value to InsuranceMarket.ae policyholders, who will now enjoy exclusive offers on home collection for health check-up packages, blood tests, and more. At InsuranceMarket.ae, we continue to champion customer experience and value proposition, and this partnership allows us to take a significant step forward in that journey."
The collaboration between Thumbay Labs and InsuranceMarket.ae represents a significant step forward in enhancing access to quality healthcare services in Dubai and the UAE. It underscores both organizations' commitment to ensuring the well-being of individuals and providing them with the financial protection they need to face any medical challenge.
NEWS JULY.AUG 2023 14
BY LEVERAGING THEIR RESPECTIVE STRENGTHS AND RESOURCES, THE TWO ORGANIZATIONS STRIVE TO CREATE A MORE INTEGRATED AND ACCESSIBLE HEALTHCARE ECOSYSTEM IN DUBAI AND THE UAE, ULTIMATELY BENEFITING THE COMMUNITY AT LARGE.
The University of Chicago Medicine Welcomes You to the Forefront




Where some of the greatest advances in medicine are hard at work for you. The University of Chicago Medicine pioneers the kind of research that’s changing lives. It is home to the most advanced medical technology, and physicians who work at the forefront of their fields.

It is our mission to bring the forefront of medicine to the world through personalized international patient services and tailored global advisory and education programs.
Clinical Centers of Excellence


» Comprehensive Cancer Center
» Transplant Institute
» Heart & Vascular Center
» Neuroscience Center
» Digestive Diseases Center
» Orthopaedic Surgery
» Obstetrics & Gynecology
» Pediatrics
For more information, visit UChicagoMedicine.org/global
100 Nobel Laureates, including 12 in Physiology or Medicine

Magnet Recognition for Excellence in Nursing & Patient Care


One of only 22 acute-care facilities nationwide to receive “A” grade in patient safety from Leapfrog Group for 21 consecutive periods as of May 2022
Ranked nationally in multiple adult and children’s specialties by U.S. News & World Report
Department of Health – Abu Dhabi announces
Cleveland Clinic Abu Dhabi and Sheikh Shakhbout Medical City as Centres of Excellence for stroke
The Department of Health – Abu Dhabi (DoH), the regulator of the healthcare sector in the Emirate, announced Cleveland Clinic Abu Dhabi and Sheikh Shakhbout Medical City (SSMC) as Centres of Excellence for stroke in the Emirate. Both facilities classify as Stroke Centres for their ability to provide high-quality and exceptional levels of stroke care through a multi-disciplinary team (MDT) of licensed and trained professionals in cerebrovascular and neurological disease across all associated disciplines including Emergency Medicine, Stroke Neurology, Interventional Neuroradiology, Cerebrovascular surgery, Diagnostic Neuroradiology and Diagnostic Radiology.
Dr. Noura Al Ghaithi, Undersecretary of the Department of Health – Abu Dhabi (DoH), said, “The Department of Health – Abu Dhabi (DoH) continues adopting a patient-centric approach when delivering world-class healthcare services, alongside enhancing the response time to all healthcare emergencies including stroke response. Through the CoE program, we aim to improve the quality of life of our community members and safeguard their health based on international standards and best practices in healthcare. Following the announcement of Abu Dhabi Stem Cells Center (ADSCC) as a centre of excellence in Hematopoietic Stem Cell Transplantation, the Department of Health – Abu Dhabi (DoH) is delighted to add Cleveland Clinic Abu Dhabi and Sheikh Shakhbout Medical City (SSMC) to its renowned list of distinguished Centres of Excellence (CoE), which establishes a high standard for excellence in healthcare and outstanding patient experience across various specialities and disciplines, which encourages a positive competition in the sector, and seeks to improve health outputs in the Emirate and beyond.”
Dr. Naser Ammash, Chief Executive Officer of SSMC said: “Being recognised as a Centre of Excellence for stroke care is a significant testa-
ment to the progress made at SSMC’s Stroke Services including Interventional Neuroradiology. Less than a year ago, we inaugurated our stateof-the-art angio suite for diagnosing and treating ischemic strokes, and we have already witnessed outstanding outcomes. During this time, we have performed many cases of Mechanical Thrombectomy. Our Integrated Multispecialty Practice, supported by Education, Research and Innovation, enables our experts to deliver a unique and timely comprehensive multidisciplinary care for a wide range of common and complex neurological conditions. At SSMC, we work to exceed international standards and patient expectations while responding to the community’s needs. We are guided by the support of the country’s leadership to propel its healthcare sector forward on a path of medical excellence and world-class patient care. It is a privilege to be designated by the Department of Health – Abu Dhabi as a dedicated Center of Excellence for Stroke in Abu Dhabi. We aspire to cement the Emirate’s position as a leading destination for complex care in the region and beyond.”
Dr. Mumtaz Khan, Chief of Staff and Acting Chief Medical Officer at Cleveland Clinic Abu Dhabi, said: "We are proud that the Department of Health – Abu Dhabi has recognised Cleveland Clinic Abu Dhabi as a Centre of Excellence for stroke care in the Emirate. This is a testament to the multidisciplinary team of experts, the worldclass infrastructure, and the clinical and research services that we have built at the Neurovascular Medicine Program and Stroke Centre. Our highly skilled caregivers and cutting-edge technological solutions provide the best clinical outcomes for stroke and other neurological diseases. This eliminates the need for people from the UAE to travel abroad for complex care. We will continue to work closely with the Department of Health – Abu Dhabi and other healthcare providers to transform the healthcare sector and position Abu Dhabi as a leading healthcare hub in the region.”
IN THE PRESENCE OF MANSOOR IBRAHIM AL MANSOORI, CHAIRMAN OF THE DEPARTMENT OF HEALTH – ABU DHABI (DOH), HASAN JASEM AL NOWAIS, GROUP CEO AND MANAGING DIRECTOR OF “M42” AND DR. NOURA AL GHAITHI, UNDERSECRETARY OF THE DEPARTMENT OF HEALTH – ABU DHABI (DOH), THE CENTRE OF EXCELLENCE PLAQUES WERE AWARDED AT THE DEPARTMENT’S HEADQUARTERS.
NEWS JULY.AUG 2023 16
Cancer treatment plans built around you.













When it comes to cancer treatment, you deserve a team that is focused on human-based care. Our experts get to know you, then tailor treatments to help fit your needs—which could include radiation, surgery, chemotherapy, immunotherapy, cellular therapy, genetic counseling, or a customized lifestyle management plan.
Learn more about the NCI-designated Dan L Duncan Comprehensive Cancer Center at Baylor College of Medicine at StLukesHealth.org/DLDCCC






The Orthopedic Department of Al-Ahli Hospital is the biggest Orthopedic Department in the private sector in Qatar.


We provide care for all aspects of Orthopedic Surgery and to patients of all ages.
This includes patients with fractures and all other aspects of Orthopedic conditions.


We use the latest technologies and innovations in providing this care and our doctors are very professional and caring.

Al-Ahli Hospital / Doha - Qatar +974 44898000 or +974 44898888 Doha - Qatar Accredited By The ACHS International مﺎـﻈﻌـﻟا ةدﺎـﻴـﻋ Orthopedic Clinic Realize your own strength when you come face to face with your weakness!



Doctors warn of potential health problems as UAE temperatures soar
As peak summer temperatures nudge ever closer to 50°C, doctors in the UAE are urging people to take special measures to stay healthy during the hot spell. Those working outdoors and children are most vulnerable to the health risks associated with extreme heat, and those with existing respiratory conditions should take extra care, doctors said.
“The temperatures this year are a little more than expected and we need to look at how the heat affects the body and our lungs in particular,” said Dr Sandeep Pargi, a pulmonologist at Prime Hospital in Al Garhoud, Dubai.
“We are seeing cases of pleural effusion during summer, where there is a build-up of fluid between the layers of tissue that line the lungs and chest cavity.
“There is a strong correlation with this condition and hot weather.
“Generally this is more common in people with asthma, or anyone with allergies that react to certain things like sand or dust.
HEAT STROKE AND THE EFFECTS OF DEHYDRATION ARE MORE LIKELY AS A RESULT OF TIME SPENT OUTDOORS, BUT AS THE HUMIDITY REACHES 100 PER CENT THIS WEEK, SERIOUS LUNG CONDITIONS ARE ALSO POSSIBLE
“We can keep a tab on the weather and avoid going out if it is particularly humid, especially from 11am until 3pm, usually the hottest time of day.”
Avoiding the heat is commonplace for many, but some whose jobs require them to work outside for hours at a time have little choice but to brave the searing summer temperatures.
The risk of heat stroke could become a more familiar problem in years to come if average global temperatures continue to rise.
While doctors said hospital admissions for heat stroke during summer were rare, people should be aware of the signs and symptoms and know how to respond, particularly if someone has an existing health condition.
“Thankfully we don’t see many heatstroke cases, but everyone should recognise the signs so it can be treated fast,” said Dr Ram Shukla, infectious disease specialist at NMC Royal Hospital, Sharjah.
Minister affirms commitment to pharmacy profession, enhancing role of pharmacists
Health
Minister of Health, Firas Hawari, has reiterated the Ministry's commitment to the pharmacy profession and underscored the significant role that pharmacists play in the treatment process as integral members of a unified medical team.
Speaking at the recent induction ceremony for new pharmacy graduates held at the Professional Associations Complex, Minister Hawari announced that the Ministry of Health has amended the Jordanian Medical Council Law to include clinical pharmacy within the purview of the council.
This move aligns with the Ministry's approach to fostering partnerships and enhancing the role of pharmacists across various aspects of its operations. "The Ministry has also taken steps to increase the number of appointed pharmacists and has embraced the specialization of clinical pharmacy in its hospitals. Presently, there is one pharmacist assigned per 50 beds, and efforts are underway to further reduce this ratio to one pharmacist per 25 beds," he added. Furthermore, the Minister indicated that the Ministry is actively establishing a dedicated unit for clinical studies, which will play a significant role in conducting pharmaceutical research and, consequently, involve pharmacists in this field.
NEWS JULY.AUG 2023 22

Abu Dhabi healthcare sector given new Emiratisation target for 2025
The Department of Health - Abu Dhabi (DoH) announced the Tawteen targets within the healthcare sector, calling on hospitals, clinics and other healthcare centres to increase the number of Emiratis employed.
All skilled professions from doctors, nurses and extended healthcare positions to administrative jobs such as accounting, finance, legal and human resources are options for Emiratis looking to work in the sector.
"This comes in line with the DoH efforts to support Tawteen initiatives in the healthcare sector to retain qualified national medical professionals, further cementing Abu Dhabi’s position as a leading global healthcare destination.”
The DoH will support all facilities in trying to achieve the target, utilising the Nafis scheme and associated tools for Emiratis looking to work in the healthcare sector. Nafis is a federal programme aimed at increasing the number of
THE DOH WILL SUPPORT ALL FACILITIES IN TRYING TO ACHIEVE THE TARGET, UTILISING THE NAFIS SCHEME AND ASSOCIATED TOOLS FOR EMIRATIS LOOKING TO WORK IN THE HEALTHCARE SECTOR.
Emiratis working in the private sector.
It includes the Medical and Healthcare Sector Cadres Development programme, which offers educational scholarships to citizens to enable them to obtain the qualifications required to work in health. The targets for the healthcare sector are in addition to those which were announced for the private sector.
In March, the Cabinet approved a decision to raise Emiratisation rates to 2 per cent annually for skilled jobs in the private sector, for companies with 50 or more employees. The current goal is to achieve 10 per cent by 2026.
"The Tawteen targets were implemented in healthcare facilities in Abu Dhabi to empower national competencies, allowing them to further contribute to the healthcare system, in order to enhance its outcomes and establish a competitive knowledge-based economy in the Emirate," said Dr. Noura Al Ghaithi, DoH undersecretary.
Cleveland Clinic Abu Dhabi’s bariatric surgery program treats over 3,200 patients with complex chronic conditions
Cleveland Clinic Abu Dhabi, an M42 company, has reached a significant milestone as its Bariatric Surgery Program completes over 3,200 surgeries since the start of the program in 2017. Cleveland Clinic Abu Dhabi's milestone of completing over 3,200 surgeries demonstrates its levels of clinical excellence in driving bariatric surgery as a successful treatment option for obesity and related comorbidities.
Dr. Javed Raza, Director of Metabolic and Bariatric Surgery and Staff Physician in the Digestive Disease Institute at Cleveland Clinic Abu Dhabi, states: “The prevalence of obesity is on the rise. It impacts vital organs such as the kidneys, heart and reproductive system, leading to
CLEVELAND CLINIC ABU DHABI'S MILESTONE OF COMPLETING OVER 3,200 SURGERIES DEMONSTRATES ITS LEVELS OF CLINICAL EXCELLENCE IN DRIVING BARIATRIC SURGERY AS A SUCCESSFUL TREATMENT OPTION FOR OBESITY AND RELATED COMORBIDITIES.
a range of health problems, including diabetes, cardiovascular disease, various forms of cancer and obstructive sleep apnea. These all significantly impact a patient’s quality of life."
Dr. Raza also emphasizes the benefits of bariatric surgery for patients struggling with obesity: “Bariatric surgery procedures include gastric bypass; sleeve gastrectomy and duodenal switch have proven to be effective treatment options for patients with chronic conditions related to obesity. Studies have shown that bariatric surgery not only helps patients achieve significant weight loss but also leads to improvement in overall health and quality of life. It is the most effective long-term and sustainable treatment for class III obesity when accompanied by important lifestyle changes.”
NEWS JULY.AUG 2023 24





@promedicholding YOUR PARTNER IN HEALTHCARE PROJECTS
As an alumnus of WCM-Q, Dr. Rizvi is coordinating the inaugural conference of the WCM-Q Alumni Association in collaboration with the college’s Division of Continuing Professional Development. The conference, titled Updates in Primary Care: Specialist-Led Case-Based Discussions Highlighting the Latest Evidence and Best Clinical Practices, will provide a comprehensive review of recent updates and practice guidelines for adult conditions commonly encountered in primary care. The event is specifically designed for family physicians, primary care physicians, and general practitioners serving the local community in Qatar’s healthcare sector. Dr. Mahrukh spoke to "HOSPITALS Magazine" to discuss the positive impact of the WCM-Q alumni community on healthcare and education in Qatar, and the scope and benefits of the first conference organized by the WCM-Q Alumni Association.
How does a thriving WCM-Q alumni community help Qatar?
Dr. Mahrukh Rizvi

Assistant Professor of Medicine, Weill Cornell Medicine-Qatar
Dr. Mahrukh Rizvi is Assistant Professor of Medicine at Weill Cornell Medicine-Qatar (WCM-Q). An alumna of WCM-Q, Dr. Rizvi graduated from the college in 2011. She then completed her residency training in Internal Medicine at Rochester Regional Health Center in Western New York where she was recognized with the Dr. U.C. Nigwekar Scholarship award for fostering the spirit of scholarship during residency. She then completed fellowships in Nephrology and Critical Care at University of Rochester Medical Center and Mayo Clinic, respectively.
Since its foundation in partnership with Qatar Foundation in 2001, WCM-Q has graduated more than 500 students, who have gone on to train in prestigious residency programs locally and internationally.
WCM-Q was the first American medical school established outside of the United States and now our thriving alumni community serves as ambassadors across the globe, embodying WCM-Q’s commitment to excellence. As an integral part of Qatar’s healthcare fabric, WCM-Q is internationally recognized through these alumni who embody our values.
The alumni community facilitates in building bridges between WCM-Q and the global healthcare landscape, serving as a catalyst for its continued success.
In essence, the alumni extend the impact of the education they received at WCM-Q beyond the confines of the physical campus. Their exceptional achievements and contributions to the frontiers of medicine also continue to inspire and cheer on the future generations
"WCM-Q WAS THE FIRST AMERICAN MEDICAL SCHOOL ESTABLISHED OUTSIDE OF THE UNITED STATES AND NOW OUR THRIVING ALUMNI COMMUNITY SERVES AS AMBASSADORS ACROSS THE GLOBE, EMBODYING WCMQ’S COMMITMENT TO EXCELLENCE."
JULY.AUG 2023 28
INTERVIEWS
"We aim to provide rigorously evidence- and case-based updates of practice guidelines for local healthcare professionals working in adult primary care."
of aspiring physicians currently receiving their education at WCM-Q.
What is the role of your alumni community in the development of Qatar's booming healthcare sector?
A little more than 25 percent of WCM-Q alumni are serving in the public and private healthcare sectors in Qatar. Many of them have completed multiple fellowships at prestigious institutions in the US, Qatar or elsewhere, specializing in unique niches that enable them to advance the intricacies of their specific fields in Qatar, both in the clinical and research realms.
These alumni bring expertise in critical areas of national priority, such as specific rheumatological conditions, specific endocrine conditions, obesity medicine, transplant medicine, interventional techniques, and more, contributing to advancements in these fields.
Moreover, we have alumni who have extended their impact beyond traditional healthcare settings by becoming influential social media figures. Through their platforms, they actively advocate for public health, sharing knowledge with Arabic-speaking audiences about diseases of national importance and dispelling misinformation.
This digital presence of our alumni empowers the population of the Qatar as well as the region to actively engage in their own health and wellbeing.
In addition to excellence in patient care, our alumni are actively involved in medical education in Qatar, serving as faculty members across various disciplines at esteemed institutions such as WCM-Q, Hamad Medical Corporation, Sidra Medicine, and Aspetar. We have alumni who are now program directors of residency and fellowship programs, shaping the future generation of physicians in Qatar.
Our alumni are also involved in the development and delivery of symposia and webinars for healthcare professionals, capitalizing on their network to invite expert presenters on timely topics. Furthermore, we have alumni in Qatar who contribute to research, driving advancements and knowledge generation in various fields, with global impact.
What are the WCM-Q Alumni Association’s aims for its inaugural conference event, ‘Updates in Primary Care’?

We have many aims with the conference but the principal objectives are twofold. Firstly, we aim to provide rigorously evidence- and case-based updates of practice guidelines for local healthcare professionals working in adult primary care.
Staying up to date with practice guidelines is very important for primary care physicians, but it is extremely challenging because of the time commitments they have to their patients. Our aim is to present these updates in an extremely efficient format that combines presentations with opportunities for discussions to clarify new terms, concepts and the evidence supporting new models of best practice.
Secondly, we aim for the conference to establish the Alumni Association as a provider of very high-quality professional development opportunities under the remit of WCM-Q’s wellestablished Division of Continuing Professional Development.
What do you feel are the factors that have allowed WCM-Q alumni to build such successful careers?
Qatar Foundation’s (QF) visionary leadership, plus WCM-Q’s leadership’s commitment to expanding our global network, and the college’s robust curriculum have been instrumental in empowering students and laying a strong foundation for their journey towards highly successful careers.
The unique opportunities available to WCM-Q medical students, such as engaging with Qatar’s tremendously diverse community, pursuing philanthropic endeavors in underprivileged nations, and gaining valuable clinical experience in the United States, foster cultural humility, cultural competence, and adaptability.
These are some indispensable attributes in a budding physician. In addition, our students
"OUR ALUMNI ARE ALSO INVOLVED IN THE DEVELOPMENT AND DELIVERY OF SYMPOSIA AND WEBINARS FOR HEALTHCARE PROFESSIONALS, CAPITALIZING ON THEIR NETWORK TO INVITE EXPERT PRESENTERS ON TIMELY TOPICS. FURTHERMORE, WE HAVE ALUMNI IN QATAR WHO CONTRIBUTE TO RESEARCH, DRIVING ADVANCEMENTS AND KNOWLEDGE GENERATION IN VARIOUS FIELDS, WITH GLOBAL IMPACT."
INTERVIEWS
29
benefit from engaging in our outstanding biomedical research program, networking opportunities, and leadership initiatives, which further enhances their preparation.
The college embraces state-of-the-art technology for education and ultimately the students are equipped to propel forward seamlessly upon graduation, building successful careers in patient care, medical education, and research, exemplifying excellence in their chosen domains locally and globally.
The continued engagement of our growing alumni community, comprising over 500 graduates, further contributes to the collective success of our esteemed graduates. This synergy, akin to a domino effect, amplifies the impact of the vision that was envisioned two decades ago.
For more information about the Updates in Primary Care: Specialist-Led Case-Based Discussions Highlighting the Latest Evidence and Best Clinical Practices conference and other WCM-Q continuing professional development activities, visit: https://qatar-weill.cornell.edu/ continuing-professional-development/
WCM-Q’s CPD activities are accredited internationally by the Accreditation Council for Continuing Medical Education (ACCME) and locally in Qatar by the Ministry of Public Health’s Department of Healthcare Professions – Accreditation Section.

INTERVIEWS
JULY.AUG 2023 30
"WE AIM FOR THE CONFERENCE TO ESTABLISH THE ALUMNI ASSOCIATION AS A PROVIDER OF VERY HIGH-QUALITY PROFESSIONAL DEVELOPMENT OPPORTUNITIES UNDER THE REMIT OF WCM-Q’S WELLESTABLISHED DIVISION OF CONTINUING PROFESSIONAL DEVELOPMENT."

Jordanian Health Minister Joins Educational Symposium on Cystic Fibrosis Patient Care

Minister of Health Firas Hawari has expressed the ministry's dedication to tackling the challenges and hindrances facing cystic fibrosis patients in Jordan. Through comprehensive treatment plans and careful monitoring, the Ministry of Health aims to mitigate the disease's symptoms, minimize complications, enhance patient lifespan, and uplift their quality of life, despite the absence of a definitive cure so far, he said.
These remarks were made during an educational event sponsored by the minister, intended for families of patients. The event focused on effective patient care and was coordinated by the Middle East Cystic Fibrosis Association, in collaboration with the Jordan Cystic Fibrosis Friends Charity.
Hawari underscored the necessity of fostering community engagement and promoting knowledge exchange at local and regional levels. The ultimate goal is to equip patient families with the tools they need to manage the disease, encompassing infection control, physiotherapy, nutritional guidelines, and the pathway to specialized health services.
unturned to source necessary medications and advanced diagnostic methods for detecting the disease and its genetic variants, in association with the Saudi Food and Drug Administration and numerous international agencies.
Hawari acknowledged that the ministry equipped hospitals with lung function testing devices approximately a year ago, thanks to a joint grant. These devices are instrumental in diagnosing and tracking the disease's progression, and in assessing treatment effectiveness.
The ministry also organized training for technical personnel to operate these devices, in partnership with a project to enhance health service quality.
Remarkably, the Ministry of Health launched lung function labs in the north, center, and south of the Kingdom in five governmental hospitals about a year ago. These labs buttress treatment centers established by the Ministry in three of them, staffed with dedicated teams specializing in the disease.
THE VISITING MEDICAL TEAM EXPRESSED A KEEN INTEREST IN WORKING HANDIN-HAND WITH THEIR JORDANIAN COUNTERPARTS, EMPHASIZING THE NECESSITY OF PERSISTENT EFFORTS AND COLLABORATIVE WORK TO ELEVATE HEALTHCARE STANDARDS IN THIS DOMAIN
The ministry has set up both a national and a technical steering committee to oversee patient care. The National Committee, comprising distinguished healthcare professionals from the Ministry of Health, Jordanian universities, the Royal Medical Services, and the private sector, has initiated a national registry to track the disease's prevalence, patient demographics, treatment locations, and requisite treatments, ensuring ongoing and suitable services.
Hawari emphasized the forthcoming electronic platform to guarantee the continuous operation and data updating of the National Cystic Fibrosis Registry. This will be undertaken in cooperation with the Improving Health System Quality project, funded by the US Agency for International Development.
The Health Minister assured that the Ministry is using all available resources to provide healthcare services to all, leaving no stone
A specialized cystic fibrosis medical team arrived in Amman from the United States as part of a volunteer medical mission, aiming to share and acquire knowledge to augment the quality of healthcare for affected individuals.
The visiting delegation, consisting of pulmonary and digestive disease experts, nurses, physiotherapists, nutritionists, and psychologists from top-tier American hospitals and medical centers, will stay for roughly a week. Their visit marks a joint effort between the Middle East Cystic Fibrosis Association and the Cystic Fibrosis Foundation in the United States.
The American medical team is eager to boost medical capacities in Jordan and enhance patient care via collaborative training sessions, seminars, and workshops at various Jordanian health facilities. This partnership envisions the establishment of a robust network of cystic fibrosis centers across the Kingdom. The aim is to deliver healthcare that amalgamates resources and expertise to affect significant advancements in patient care, thereby positively impacting individuals and families battling the disease.
NEWS JULY.AUG 2023 32






















3rd Edition of the Saudi International Pharma and Medlab Expo يدﻮــﻌــﺴﻟا ضﺮــﻌــﻤﻟا ﺔـــﻟﺪـــﻴﺼــﻠﻟ ﻲـــﻟوﺪــــﻟا www.saudimedlabexpo.com www.saudipharmaexpo.com P.O Box 295771 | Riyadh 11351, Office # 7, 2nd Floor Next Al Moosa Center Main Olaya Street, Riyadh KSA T : +(966) 9 200 200 25 | F : +(966) 11 204 4454 Email : info@saudipharmaexpo.com | info@saudimedlabexpo.com (966) 55 135 6818 Organized by Riyadh International Convention & Exhibition Centre 9 - 11 Oct, 2023 Early Bird Registration REGISTER NOW Medlab Pharma




The Healthcare Financial Management Association (HFMA) has more than 96,000 members who seek education, networking, and career guidance.



Join as an international member of HFMA and get access to unlimited online content, select webinars and podcasts and discounts on education and conferences.
hfma.org/international

We help healthcare financial management professionals succeed.

Candida Auris
Drug-resistant fungal infection
Candida auris is a drug-resistant fungus, making it one of the most challenging infections. These fungal species cause outbreaks in healthcare settings, so it is essential to quickly identify the presence of Candida auris in patients, especially those who spend long periods in healthcare facilities, intensive care units, or nursing homes, to take special precautions to stop its spread.
Candida auris, also known as "white spot disease," is classified as a type of yeast that poses a threat to individuals with weakened immune systems if it enters the bloodstream and spreads throughout the body, according to the Centers for Disease Control and Prevention. The infection can result in the death of 30 to 60 percent of those affected.

On the other hand, diagnosing this type of fungus requires specialized laboratory equipment, and treating it is difficult due to its resistance to common antifungal drugs, which exacerbates the severity of this problem. Therefore, improving diagnostic methods can contribute to the early detection of Candida auris in infected individuals, ensuring that patients receive the appropriate treatment promptly and preventing the transmission of the infection from person to person. Centers for Disease Control and Prevention are increasingly concerned about this type of fungus, as it has recently shown the ability to resist multiple drugs and treatments, and it is difficult to identify in laboratories or easily misidentify due to the need for specialized techniques for diagnosis. This poses a danger as it contributes to the rapid spread of the infection.
MAINTAINING CLEANLINESS REMAINS THE OPTIMAL SOLUTION TO CONTROL AND PREVENT THE SPREAD OF THE MICROBE. EARLY DETECTION IS CRUCIAL FOR THE PATIENT AND THE HOSPITAL.
JULY.AUG 2023 42 ARTICLE FEATURES . Accreditation
What is Candida Auris?
Candida auris is a type of microbial fungus that can be transmitted through human infections. It is associated with what is known as "white internal fungi," which are common fungi that cause oral infections, for example.
It was first discovered in the ear canal of a Japanese patient at the Tokyo Metropolitan Geriatric Hospital in 2009, where these fungi grow as colonies. It is one of the few species of the Candida family that causes white spot disease in humans. Often, infections with white spot disease occur in hospitals among patients with weakened immune systems.
Most of the time, Candida auris lives on the skin's surface without causing any problems, but it can cause infections when we feel tired or sick or when the microbe enters places like the
bloodstream or the lungs.
The fungus can spread in elderly care homes and nursing facilities, causing outbreaks in healthcare settings through contact with infected patients, surfaces, or contaminated equipment. It is also resistant to standard cleaning fluids and disinfectants, which increases its severity and ease of transmission.

Moreover, it can enter the bloodstream and spread throughout the body, causing severe infections in the respiratory system, central nervous system, and internal organs such as the kidneys, liver, spleen, skin, and eyes. Patients who stay in hospitals for long periods, have central venous catheters or other inserted tubes, or have received antibiotics or antifungal medications in the past are more susceptible to the risk of infection with this fungus.
MOST OF THE TIME, CANDIDA AURIS LIVES ON THE SKIN'S SURFACE WITHOUT CAUSING ANY PROBLEMS, BUT IT CAN CAUSE INFECTIONS WHEN WE FEEL TIRED OR SICK OR WHEN THE MICROBE ENTERS PLACES LIKE THE BLOODSTREAM OR THE LUNGS.
43 Accreditation . ARTICLE FEATURES
What are its complications?
The fungus Candida auris can cause serious bloodstream infections and affect the respiratory and nervous systems, internal organs in the human body, and the skin.
It often does not respond to commonly used antifungal medications typically used to treat Candida infections. Some strains are resistant to three types of antifungal drugs, making it extremely difficult to treat the diseases.
This type of fungus can cause a deadly condition known as invasive candidiasis, which affects the bloodstream, central nervous system, and internal organs.
How does it spread?
The risk of infection increases when staying in healthcare facilities for a long time. According to the Centers for Disease Control and Prevention, it is unlikely to acquire Candida auris infection in everyday life.
It primarily spreads through contaminated hospital surfaces and can adhere to intravenous catheters and blood pressure monitoring devices. With this type of fungus, surface cleaning becomes highly challenging. Often, the solution is to close entire units or sections.
How can we prevent the spread of Candida auris?

Cleanliness and sanitation are crucial steps in prevention. Anyone who interacts with the patient and has direct contact should maintain hand hygiene by washing hands with soap or using sanitizers before and after touching the patient infected with the fungus, as well as their equipment and belongings in their room.
Healthcare workers should pay continuous attention to hand hygiene, wear personal protective clothing, and thoroughly clean the patient's room.
Medical laboratory professionals should know how to identify fungal infection cases, isolate and identify them promptly to prevent their spread among patients. Additionally, reporting new cases to health authorities is essential for early monitoring of its spread in healthcare facilities.
Maintaining cleanliness remains the optimal
solution to control and prevent the spread of the microbe. Early detection is crucial for the patient and the hospital. Healthcare providers and workers in the healthcare field should pay greater attention to patients who spend a long time in hospitals, especially those with compromised immune systems, as they face a higher risk of infection with this microbe.
World Health Organization (WHO)
The World Health Organization recently classified 19 types of fungi as the greatest threats to public health. Including these fungi aims to enhance research efforts, improve the response to fungal infections, and combat antifungal resistance.
Candida auris, a type of white spot fungus, is among the fungi that pose a health risk. The organization has warned that new groups risk developing invasive fungal diseases, and continuous identification is necessary.
Among its key recommendations for countries addressing fungal diseases, the World Health Organization emphasizes the need to strengthen laboratory capacities and surveillance to better understand the burden of infection and antifungal resistance. The organization states that "antifungal drug resistance is partly driven by inappropriate use of antifungal agents," noting that misuse of antifungals has been associated with increased infections caused by Aspergillus fungi, also known as "smoke fungus," which has a broad capacity for spreading.
ARTICLE FEATURES . Candida Auris JULY.AUG 2023 44
AMONG ITS KEY RECOMMENDATIONS FOR COUNTRIES ADDRESSING FUNGAL DISEASES, THE WORLD HEALTH ORGANIZATION EMPHASIZES THE NEED TO STRENGTHEN LABORATORY CAPACITIES AND SURVEILLANCE TO BETTER UNDERSTAND THE BURDEN OF INFECTION AND ANTIFUNGAL RESISTANCE.
ULTRAVIOLET-C (UVC) RADIATION IS CONSIDERED THE MOST EFFECTIVE STERILIZATION METHOD, AS IT DEACTIVATES VIRUSES AND BACTERIA AND REDUCES THE RISK OF INFECTION.

Advanced devices for infection control
Ultraviolet-C (UVC) radiation is considered the most effective sterilization method, as it deactivates viruses and bacteria and reduces the risk of infection. Studies in this field have shown that UVC can successfully disinfect an area from Candida auris infection with more prolonged exposure and at close range.
Studies in this field have demonstrated the remarkable effectiveness of UVC disinfection in preventing the spread of the disease. Through rigorous microbiological analysis following the British standard for evaluating UVC disinfection devices, they have shown the ability to eliminate Candida auris efficiently.
Hospitals or healthcare facilities need to recognize the importance of using this method for disinfection to reduce Candida auris infection, protect critical environments, and address the antimicrobial threat within their premises. Unfortunately, this type of yeast has a high survival rate on solid surfaces, potentially lasting for weeks.
However, integrating surface disinfection using UVC devices alongside proper hand hygiene practices can significantly impact the spread of harmful microorganisms.
Candida Auris . ARTICLE FEATURES
45
Mr. Nasib Nasr
General Director of Hôtel-Dieu de France
The aftermath of the Beirut Port explosion in August 2020, coupled with the nation's ongoing financial crisis, has left Lebanon on the brink of collapse. Moreover, many sectors were impacted by this situation, especially Lebanon's health sector, which heavily depends on public coverage. In the hope of shedding additional light on this subject, ‘Hospitals’ magazine interviewed Mr. Nasib Nasr, General Director of Hôtel-Dieu de France, one of the most prestigious hospitals in the country, administered by Saint Joseph University of Beirut.
What are the main concerns in regard to the healthcare sector in Lebanon today?
One of the primary obstacles today is the lack of public health coverage in Lebanon, the country's current economic situation, as well as the scarcity of some drugs and other medical supplies.
With the huge decline in access to healthcare services in Lebanon, what role do Hôtel-Dieu de France and the USJ-HDF hospital network play in helping people get the needed services?
One of our main roles is maintaining some of our previous, extremely high standards for healthcare, which is difficult. It is no simple task. However, I believe that the danger zone has been crossed. In order to get through this crucial period, we have worked hard to save three other medium hospitals, which are now administered by Hôtel-Dieu.
Today, we have the largest network of hospitals and hospital beds in Lebanon that meet quality standards, which is difficult to have given what is happening in Lebanon.
What are the positive and negative sides of creating a hospital network in Lebanon?

The positive side is that we are creating a synergy between hospitals, and in doing so, we can optimize a variety of things, including services, third-party payments, supplies, etc. The drawback is that we are in charge of three additional hospitals, all of which have a very poor financial history, and we must invest in them to help them get back to where they were before the crisis. We thus have a plan, and the first phase of it consists of helping them and investing in them. I believe we will see results in the next upcoming months.
What is your vision regarding Hôtel-Dieu de France and its hospital network?
First and foremost, the hospital network, which is quite dynamic, will expand both this year and in the years to come. We are currently developing a number of projects, which include hospitals and many other ideas.
Moreover, our country requires additional hospital beds with administration similar to that of Hôtel-Dieu because other hospitals are in such poor conditions. Second, the social responsibility of Saint-Joseph University of Beirut and Hôtel-Dieu de France will be marked by a very critical period where we will support people and make it easier for them to have access to healthcare services.
ONE OF OUR MAIN ROLES IS MAINTAINING SOME OF OUR PREVIOUS, EXTREMELY HIGH STANDARDS FOR HEALTHCARE, WHICH IS DIFFICULT. IT IS NO SIMPLE TASK. HOWEVER, I BELIEVE THAT THE DANGER ZONE HAS BEEN CROSSED. IN ORDER TO GET THROUGH THIS CRUCIAL PERIOD, WE HAVE WORKED HARD TO SAVE THREE OTHER MEDIUM HOSPITALS, WHICH ARE NOW ADMINISTERED BY HÔTEL-DIEU.
JULY.AUG 2023 46
INTERVIEWS
"The hospital network will expand this year and in the years to come."
Is the healthcare sector still in decline today, or is it getting better?
It is still declining, perhaps more slowly than before, and it will continue to decline until there is new governance in the country as well as a different political and economic situation, because they are closely related to what is happening outside the hospital.
Indeed, Lebanon depends on public coverage, as 40% to 50% of the Lebanese population is covered by the army, the ISF, and the public social security system. The latter, however, is gradually disappearing.
Having been ranked 23rd worldwide for healthcare efficiency in 2019, can Lebanon still be considered a country where healthcare services are top-tier today?
The country’s situation is dire. I don’t think Lebanon has the same rank as before internationally.
However, our hospital and our hospital network are ranked, if not first, second in the country and in the region in terms of quality healthcare.
Lebanon is known for its top healthcare services, with people worldwide coming there to receive top-notch care and treatments. Did the healthcare sector witness a decline in people coming to Lebanon to access such services because of the economic crisis?

Yes, and it's mostly because of a political issue with all of the surrounding countries, not just because of the economic crisis. Nowadays, no one from the Gulf countries or the surrounding areas travels to Lebanon for tourism. The same applies to medical care. Today, people from the Gulf countries do not travel to Lebanon for medical treatment, as they have better, higher quality medical care. They are building their hospitals, thus replacing Lebanon as a medical care hub, and in doing so, they are taking a lot of doctors and nurses from our country. So, yes, it is difficult to maintain something that is not maintainable.
FIRST AND FOREMOST, THE HOSPITAL NETWORK, WHICH IS QUITE DYNAMIC, WILL EXPAND BOTH THIS YEAR AND IN THE YEARS TO COME. WE ARE CURRENTLY DEVELOPING A NUMBER OF PROJECTS, WHICH INCLUDE HOSPITALS AND MANY OTHER IDEAS.
INTERVIEWS
47
Dr. Ziad Zakaria

MD, FACS, Endocrine Surgery at Clemenceau Medical Center - Beirut
The thyroid gland is part of the endocrine system, which is made up of glands that secrete various hormones into the bloodstream. Thyroid nodule refers to an abnormal growth of thyroid cells. "Hospitals" Magazine met Dr. Ziad Zakaria, MD, FACS, Endocrine Surgery at Clemenceau Medical Center – Beirut, who talked about thyroid nodules.
What are thyroid nodules?
Thyroid nodules are solid lumps that form within the thyroid, a gland located in the neck.
The thyroid gland is part of the endocrine system, which is made up of glands that secrete various hormones into the bloodstream. The thyroid resembles a butterfly located on the front of the neck. The thyroid gland, which is made up of a right lobe and a left lobe, produces thyroid hormones that control many organs like the heart, the skin, the central nervous system, liver and bones.
What causes thyroid nodules?
Nodules develop more often in people who have a family history of nodules, people lacking iodine in their diet, people exposed to radiation, air pollutants or chemicals.
When there are many nodules in the thyroid, we call it multinodular goiter, the nodules can have different sizes or shapes, they can harbor what we call microcalcifications. Cancer is the biggest concern when nodules form, and we may request a biopsy to differentiate between benign or cancerous nodules.
What about the symptoms ?
Neck discomfort, sensation of shortness of breath, lump showing on the neck, increase in size over time, trouble swallowing
THE THYROID GLAND IS PART OF THE ENDOCRINE SYSTEM, WHICH IS MADE UP OF GLANDS THAT SECRETE VARIOUS HORMONES INTO THE BLOODSTREAM.
Hyperthyroidism:
Sometimes the nodules produce excessive thyroid hormone what we call hyperthyroidism. Hyperthyroidism can cause rapid heart rate, hypertension, high blood pressure, eye protrusion, nervousness, sweating and other medical problems.
Hypothyroidism:
Sometimes the thyroid nodules present within an underactive thyroid gland which means the levels of the thyroid hormone are low. Hypothyroid status can cause fatigue, hair loss, unable to concentrate, memory problems, weight gain, constipation and other medical problems.
How are thyroid nodules diagnosed?
• Thyroid ultrasound
• Blood test to check the thyroid hormone level
• Biopsy of the thyroid gland in order to determine the nature of a nodules and to have an accurate diagnosis
• Thyroid scan
Treatment:
Treatment depends on the type of nodule and of the level of the thyroid hormones in the blood.
INTERVIEW INTERVIEWS
JULY.AUG 2023 48
"Treatment of thyroid nodule depends on its type and the level of the thyroid hormones in the blood"
1. Surgery: We perform surgery if the nodules are causing symptoms or if a nodule is cancerous on biopsy or shows atypical cells (suspicious).
2. No treatment If the nodules are small not causing any symptoms and not cancerous, we follow the patient on a regular basis to look for any changes in the nodules.
3. Hyperthyroidism, excess thyroid hormone secretion: Antihormone medication is prescribed or sometimes radioactive iodine,
CANCER IS THE BIGGEST CONCERN WHEN NODULES FORM , AND WE MAY REQUEST A BIOPSY TO DIFFERENTIATE BETWEEN BENIGN OR CANCEROUS NODULES.
if the thyroid is not responding to the usual medication.
4. Hypothyroidism, underactive thyroid gland: We prescribe thyroid hormone replacement tablets.

49 INTERVIEWS
Protected time for pharmacists to educate patients about their medications, to check for polypharmacy and to review opportunities for deprescribing medications can be created and secured by the introduction of automation. 7

Sustainability & Healthcare: A Choice and an Urgent Necessity in Medication Management.
James Waterson. RN, M.MedEd, MHEc. Medical Affairs Manager, Medication Management Solutions. Becton Dickinson Middle East and Africa.
Aya Idriss. BSc. Product Specialist, Medication Management Solutions. Becton Dickinson Middle East, North Africa, and Turkey.
Tarek Kassab. MSc, MD. Market Access & Strategy Leader. Medication Management Solutions. Becton Dickinson Middle East, North Africa, and Turkey.
The Direct Challenge
One of the biggest challenges facing us today right across the healthcare continuum is sustainability. This means physically reducing the carbon footprint of healthcare, and reducing the consumption of plastics in the form of disposables and sterile packaging of medical supplies. This is undoubtedly important and at Becton Dickinson we strive to achieve these very clear
goals through vigilant supplier oversight for adherence to applicable environmental laws and regulations. We also aim to optimize the environmental performance of products and operations and take a life-cycle approach for all products.
BD is committed to making strong efforts to reduce the consumption of energy, water, and other nonrenewable natural resources, as well as
BD IS COMMITTED TO MAKING STRONG EFFORTS TO REDUCE THE CONSUMPTION OF ENERGY, WATER, AND OTHER NONRENEWABLE NATURAL RESOURCES, AS WELL AS MINIMIZING, MEASURING AND REPORTING WATER AND AIR DISCHARGES INTO THE ENVIRONMENT.1
ARTICLES JULY.AUG 2023 50
minimizing, measuring and reporting water and air discharges into the environment.1
The ‘Indirect’ Challenge.
At Becton Dickinson we view sustainability as a portfolio of complementary initiatives and actions that helps us achieve our purpose of Advancing the World of Health™. Our 2030+ sustainability strategy addresses a range of challenges in our industry while helping to make a difference on relevant issues that affect society and the planet.2
Of course, all of us working in healthcare have always had a responsibility to society and to our patients and to the individuals we work with in our healthcare facilities to deliver and sustain the highest quality of care right across the patient experience, from admission to discharge, and beyond. But now more than ever ecological and human sustainability needs to be built into every patient interaction. By putting sustainability front and centre in our approaches to patient care we can ‘build back’ into the system through managing care efficiently. Applying technology to care can help to reduce waste in terms of our human resources, facility resources in terms of Length of Stay (LOS), pharmaceutical and surgical treatment resources, and community resources.
BD works to strengthen healthcare systems across the world by developing and deploying market-appropriate solutions, and BD Global Public Health works to align activities, priorities, and development efforts around the world's leading public health needs. We drive access to existing BD solutions and develop and deploy innovations to address priority health needs in areas aligned with Sustainable Development Goals (SDGs).3
Sustainability and Medication Management Solutions
Medication management has, as its core goal, avoiding iatrogenic harm. One example of this is planning for successful discharge, avoiding ‘bounce back’ readmission, and reducing the risk of self-medicating patients taking medications incorrectly, or not adhering to medication regimens due to lack of understanding. The question
is how can we create this time for teaching and engaging with patients to take place in a busy outpatient pharmacy department?
A robotic and automated pharmacy may help us achieve the goal of protecting time for pharmacists to undertake techniques like ‘teach back’, and also review medication regimens for potential deprescribing and dangerous polypharmacy during discharge planning or outpatient education and help to ensure that patients adhere to medication regimens. A program of medication counselling and education may help reduce the ‘bouncing back’ we currently see, with one study showing that 14.7% of emergency admissions in Saudi Arabia were related to medications being taken incorrectly at home.4
Protected time for pharmacists to educate patients about their medications, to check for polypharmacy and to review opportunities for deprescribing medications can be created and secured by the introduction of automation. 7

Such events cost the system, cost social healthcare budgets, and cost the environment with the opportunity cost of dispensing never used, or incorrectly used, pharmaceuticals. To achieve this aim of pharmacists and nurses being able to spend more time on direct care and patient education we need to reduce the Non-Value Added (NVA) tasks that pharmacists and nurses undertake so that they can do the things they were trained to do. The 2016 study of Fisher et al suggested that pharmacists spend more than fifty percent of their time in traditional medication management systems in NVA tasks such as inventory, medication ordering, or
A ROBOTIC AND AUTOMATED PHARMACY MAY HELP US ACHIEVE THE GOAL OF PROTECTING TIME FOR PHARMACISTS TO UNDERTAKE TECHNIQUES LIKE ‘TEACH BACK’, AND ALSO REVIEW MEDICATION REGIMENS FOR POTENTIAL DEPRESCRIBING AND DANGEROUS POLYPHARMACY DURING DISCHARGE PLANNING OR OUTPATIENT EDUCATION AND HELP TO ENSURE THAT PATIENTS ADHERE TO MEDICATION REGIMENS.
ARTICLES 51
undertaking double-checks on forecasts.5
We often think of waste in terms of discarded plastics and ‘simple’ extravagance or carelessness, but West’s Delphi panel of 2015 gave a stark warning on the impact of medication wastage and a very comprehensive description: ‘Medication wastage refers to any medication which expires or remains unused throughout the whole medicines supply chain. It also refers to the unnecessary or inappropriate consumption of medications by patients, or the unjustified non-adherence to treatment guidelines by healthcare professionals. Medication wastage poses a financial burden on patients themselves and the state's economy and requires adequate education of all people concerned’.6 Medications are expensive for the organization and for society in simple monetary terms, but of course there is also an environmental cost and extensive use of ecological resources in the production of pharmaceuticals which can be wasted if the patient is non-adherent, if medications are given incorrectly, and of course if stock is not handled efficiently and pharmaceuticals expire in the facility.
Preservation of medication supply by reducing the risk of expiry can be substantially improved by the use of robotic pharmacies as the system takes in the expiry date along with other medication data via barcode reading and as it loads the secure storage area it looks for special precautions such as refrigeration requirements


and arranges and rotates medications by expiry date and creates a dynamic inventory with alerts for slow moving items and near-expiry products. A 2022 outpatient study that assessed wastage via a ‘basket’ of sample medications, found expired medication wastage cost was reduced by 83.9% following the introduction of a BD Rowa™ robotic pharmacy for management and dispensing.7
Waste reduction of expensive and complex medications can also extend into intravenous medication compounding, particularly in the oncology field where sustainability is vital8 as the global ‘load’ for IV-chemotherapy cancer treatments is estimated to increase from a 2018 baseline by 53% (from 9.8 million to 15 million individuals) by 2040.9
A gravimetric compounding solution such as BD Cato™ which can reduce the risk of compounding error (and the obligatory discarding of incorrectly compounded products) not only makes financial sense, it is also contributing to overall sustainability of oncology care. A well-constructed and extensive study in 2019 found the volume of potentially incorrectly compounded oncology products with a greater than 20% tolerance error for incorrect dose to be as high as 7.89% of all compounded products.10 When using BD Cato™ the clean room technician is also supported by the software to choose the most sustainable and economical option in
A GRAVIMETRIC COMPOUNDING SOLUTION SUCH AS BD CATO™ WHICH CAN REDUCE THE RISK OF COMPOUNDING ERROR (AND THE OBLIGATORY DISCARDING OF INCORRECTLY COMPOUNDED PRODUCTS) NOT ONLY MAKES FINANCIAL SENSE, IT IS ALSO CONTRIBUTING TO OVERALL SUSTAINABILITY OF ONCOLOGY CARE.
ARTICLES JULY.AUG 2023 52
Systems such as automation of individual dosing and dynamic inventory robotic pharmacies can substantially reduce the financial and ecological harm created by unnecessary expiry of medications. 7
An estimated 15 million individuals will be undergoing IV-chemotherapy cancer treatments globally by 2040.9 Increasing productivity of oncology compounding units via technologies such as BD CatoTM is vital in order to sustain our ability to provide this care.11

terms of the menu of ampoule size selection for optimum dosing and the ability to optimally reuse partial ampoules of these high-value medications.
The compounding clean room is an engine room of productivity in IV-medication cancer care, and we need to think about the sustainability of technicians and pharmacists working in this area. Healthcare is a highly human industry, and it takes a heavy load on the people working within it. Technology can assist not only with reducing NVA, and potentially error loaded, tasks such as transcription from prescription to compounding order sheets, but also by supporting workflows with compounding with point of care guidance, key-step capture making review and second-check sign off easier and more effective, and through barcode label production that can track the compounded product’s journey right down to documentation of administration. A 2021 study illustrated how one oncology compounding unit increased its productivity over five years by 100% after the introduction of the BD Cato™ compounding solution without a change in employee headcount.11
Automating Community Services for Sustainability
When we look at the value given by the different services available in healthcare systems we need to think expansively and in terms of the econometrics of how we serve patients to maximize cost effectiveness, but also to ensure sustainability by making our cost analysis at a societal level. For example, community pharmacies and retail pharmacies have a potentially strong role to play in making healthcare sustainable by undertaking primary healthcare functions such as running weight reduction clinics, smoking cessation courses, diabetic care assessments and so on.
These retail and community pharmacies are potentially powerful agencies in maintaining the sustainability of healthcare systems. It is a logical extension to link them and integrate them into the processes of prescribing and medication management we already see in our large university and specialist hospitals and medical cities. Then, through applying automation in retail and community pharmacies to manage orders and inventory, we can free these professional
WHEN USING BD CATO™ THE CLEAN ROOM TECHNICIAN IS ALSO SUPPORTED BY THE SOFTWARE TO CHOOSE THE MOST SUSTAINABLE AND ECONOMICAL OPTION IN TERMS OF THE MENU OF AMPOULE SIZE SELECTION FOR OPTIMUM DOSING AND THE ABILITY TO OPTIMALLY REUSE PARTIAL AMPOULES OF THESE HIGH-VALUE MEDICATIONS.
ARTICLES 53
Community pharmacies and retail pharmacies are potentially powerful agencies in maintaining the sustainability of healthcare systems. Integrating them into processes of prescribing and medication management, and applying automation can free pharmacists to take on extra services to serve patients better and more locally.
pharmacists to take on extra services to serve patients better and more locally.

‘Localization’ through making smaller scale pharmacies as efficient as those already automated in large centrally located facilities works at another level of sustainability. Talking about the traffic for residents of our great cities in the Middle East is like talking about the weather for the English, and our cities are choked with automobiles. Connected and automated medication management for patients who are at home via community outlets and via ATM style medication dispensing units backed by BD Rowa™ medication storage and picking technology with telehealth support from pharmacists potentially reduces unnecessary car trips for medication refills to city central hospitals.
Over the last fourteen years, humanity has passed seven of eight safe boundaries for the Earth’s ecosystem to be able to support habitation12 and whilst air pollution remains just inside the threshold for ‘dangerous limits’ there are still 4.2 million deaths attributed to poor air quality globally per annum.12 Reducing traffic is very much a sustainability goal as it remains a substantial determinant of health in even developing economies.12 BD Cato™ technology has
also been used to allow pharmacists to undertake accurate remote checks on compounding units, this garnered $23,770 in direct annual savings with no change in the quality of the checks in one study13, and we must consider that now unnecessary commutes could also be reduced by such an approach.
Sustaining the Environment, Sustaining the Healthcare Workforce
Healthcare also contributes to greenhouse gases in another way. A 2021 paper14 concluded that in our current climate crisis, sustainable healthcare initiatives need to look at the impact of inhaled anesthetics both on the wider environment and on the direct occupational environment of Health Care Workers (HCPs). This was essentially a call to action to judiciously consider in each treatment how, when, and why volatile agents such as nitrous oxide (N2O) and desflurane are unavoidable, and whether Total Intravenous Anesthesia (TIVA) and Target Controlled Infusion (TCI) of anesthetic agents via pharmacokinetic models of the types used in BD Alaris™ Plus PK syringe pumps could be efficacious substitutes, and to invest in the development of new technologies.
CONNECTED AND AUTOMATED MEDICATION MANAGEMENT FOR PATIENTS WHO ARE AT HOME VIA COMMUNITY OUTLETS AND VIA ATM STYLE MEDICATION DISPENSING UNITS BACKED BY BD ROWA™ MEDICATION STORAGE AND PICKING TECHNOLOGY WITH TELEHEALTH SUPPORT FROM PHARMACISTS POTENTIALLY REDUCES UNNECESSARY CAR TRIPS FOR MEDICATION REFILLS TO CITY CENTRAL HOSPITALS.

ARTICLES JULY.AUG 2023 54
Total Intravenous Anesthesia could be an efficacious substitute in many surgeries for inhalational agents which contribute to greenhouse gases.14

Sustainability also means looking after each other, and we need to work systemically to create and maintain a just culture, and to make sure that the systems within our facility ‘raise up’ and support all staff and increase the chance of them doing things correctly. System failures of risk management leave clinicians exposed, and at risk of burnout, and work overload, and increase the risk of patient harm.15 Sustaining HCPs, physicians, pharmacists, and nurses, is an area where we believe technology can contribute at many levels. Creating a feeling of confidence in the system in which HCPs work and reducing the risk of medication error can be achieved through the application of Dose Error Reduction Systems for intravenous therapy16 and with Automated Dispensing Cabinets with barcode scanning for patient identification and confirmation of ‘right medication’.17 The risk of attrition and ‘burnout’ in nurses must be attend-
ed to both urgently and continually if we are to maintain a sustainable nursing workforce.18 Medication error also impacts the financial sustainability of healthcare at a societal level. The OECD estimates that 15% of annual health spending globally is used for rectifying medical error, and of the adverse events causing this loss, 18.3% of them are medication errors.19 Serious medication errors can cost $7300 and 4.8 days in extra length of stay per episode.20
MEDICATION ERROR ALSO IMPACTS THE FINANCIAL SUSTAINABILITY OF HEALTHCARE AT A SOCIETAL LEVEL.

ARTICLES 55
IV-Medication error reduction via smart pump technology16 could impact finances of facilities and the societal burden of healthcare as well as supporting staff at risk of burnout.
Sustaining Our Gains
Fleming’s discovery of Penicillin took place in 1929, so we have not sustained even one-century from this ‘game-changing moment’ before we witnessed the emergence of Antimicrobial Resistance (AMR). So how to ensure a future for this vital group of medications? The nightmare scenario has been with us for a number of years now, that the first, second, and third-line antibiotics fail against resistant organisms. Sustainable healthcare, and the ability to effectively treat patients in the future means using our skills and our technology to preserve our ammunition.
AMR control is therefore everyone’s responsibility. Reducing the risk of patients acquiring
nosocomial complications or hospital-acquired infections leading to unnecessary extensions of stay, and extra lines of antibiotics is critical. All these adverse events take resources out of the available funding, and in the case of possibly avoidable treatment for nosocomial infections we have to take account of the ecological impact of IV-cannulation and disposables for IV-medications which add extra packaging and waste plastic to the environmental cost of reparative treatment.21
Reducing risk can range from ensuring optimal selection, insertion, and care of IV-catheters, through to IV-infusion strategies aimed to ensure longevity for peripheral and central ve-
REDUCING RISK CAN RANGE FROM ENSURING OPTIMAL SELECTION, INSERTION, AND CARE OF IV-CATHETERS, THROUGH TO IV-INFUSION STRATEGIES AIMED TO ENSURE LONGEVITY FOR PERIPHERAL AND CENTRAL VENOUS ACCESS. THERE IS ALSO A STRONG ECONOMIC AND FINANCIAL ARGUMENT FOR ADDING QUALITY TO INFUSION THERAPIES22 VIA SPECIALIST PRESSURE MONITORING TECHNIQUES, FILTRATION, AND AI PREDICTED FLOWRATE MANIPULATION TO PRESERVE VENOUS ACCESS FOR AS LONG AS POSSIBLE.23

ARTICLES JULY.AUG 2023 56
nous access. There is also a strong economic and financial argument for adding quality to infusion therapies22 via specialist pressure monitoring techniques, filtration, and AI-predicted flow-rate manipulation to preserve venous access for as long as possible.23
Antibiotic stewardship is interdisciplinary- but it’s better done if we share, and if we have one common source of information that captures it all.24 Every patient’s journey is complex and BD solutions such as BD HealthSight™ Clinical and Infection Advisor that track antimicrobial usage and emergent infections in both the facility and in the community25 ensure that medication management and antibiotic stewardship data is available for collaboration and coordination of strategy between the infectious
disease and microbiology departments and the pharmacy department to manage not only the patient but also the organization’s wider goals of antibiotic stewardship, antibiotic waste reduction, and efficiency in treatment.
BD solutions for medication management aim to take away non-value-added tasks and bring information to the right place at the right time to assist in sustaining patients and sustaining healthcare for all.
Not all products, services,
products may be
or valid in your local area. Please check with your local BD Representative. The information included in this article is intended for healthcare professionals only.
References:
1. https://www.bd.com/content/dam/bdcom-assets/en/en-us/documents/policies-guidelines-and-statements/policies/bd-global-expectations-for-suppliers_english.pdf
2. https://investors.bd.com/esg/sustainability
3. https://www.bd.com/en-us/about-bd/esg?#bd-tabs-f3430fd6ed-item-86472f67ba-tab
4. Al-Olah Y, Al Thiab K. Admissions through the emergency department due to drug-related problems. Ann Saudi Med 2008;28(6):426-429.
5. Fisher AM, Ding MQ, Hochheiser H, Douglas GP. Measuring time utilization of pharmacists in the Birmingham Free Clinic dispensary. BMC Health Services Research. 2016;16(1):529. doi:10.1186/s12913-016-1787-6
6. West LM, Diack L, Cordina M, et al Applying the Delphi technique to define ‘medication wastage’ European Journal of Hospital Pharmacy 2015;22:274-279.
7. Al Nemari M, Waterson J. The Introduction of Robotics to an Outpatient Dispensing and Medication Management Process in Saudi Arabia: Retrospective Review of a Pharmacy-led Multidisciplinary Six Sigma Performance Improvement Project. JMIR Hum Factors. 2022 Oct 11;9(4):e37905. doi: 10.2196/37905. PMID: 36222805; PMCID: PMC9597422.
8. Ferrara L, Otto M, Aapro M, Albreht T, Jonsson B, Oberst S, Oliver K, Pisani E, Presti P, Rubio IT, Terkola R, Tarricone R. How to improve efficiency in cancer care: Dimensions, methods, and areas of evaluation. J Cancer Policy. 2022 Dec;34:100355. doi: 10.1016/j.jcpo.2022.100355. Epub 2022 Aug 22. PMID: 36007873.
9. Wilson BE, Jacob S, Yap ML, Ferlay J, Bray F, Barton MB. Estimates of global chemotherapy demands and corresponding physician workforce requirements for 2018 and 2040: a population-based study. Lancet Oncol. 2019 Jun;20(6):769-780. doi: 10.1016/S1470-2045(19)30163-9. Epub 2019 May 8. Erratum in: Lancet Oncol. 2019 Jul;20(7):e346. PMID: 31078462.
10. Terkola R, Czejka M, Bérubé J. Evaluation of real-time data obtained from gravimetric preparation of antineoplastic agents shows medication errors with possible critical therapeutic impact: Results of a large-scale, multicentre, multinational, retrospective study. J Clin Pharm Ther. 2017 Aug;42(4):446-453. doi: 10.1111/jcpt.12529. Epub 2017 Apr 21. PMID: 28429389.
11. Meren ÜH, Waterson J. Evaluating An Automated Compounding Workflow Software for Safety and Efficiency: Implementation Study. JMIR Hum Factors. 2021 Nov 2;8(4):e29180. doi: 10.2196/29180. PMID: 34456182; PMCID: PMC8596227.
12. Rockström, J., Gupta, J., Qin, D. et al. Safe and just Earth system boundaries. Nature (2023). https://doi.org/10.1038/s41586-023-06083-8
13. Jean SJ, Francart SJ, Eckel SF, Schenkat D, Eberwein S, Lamm M, Barnes N, Valgus JM, Amerine LB. Evaluation of telepharmacy and the use of a gravimetric technology-assisted workflow system for remote sterile product pharmacist checks. Am J Health Syst Pharm. 2020 Mar 24;77(7):560 567. doi: 10.1093/ajhp/zxaa015. PMID: 32086506.
14. Gaya da Costa M, Kalmar AF, Struys MMRF. Inhaled Anaesthetics: Environmental Role, Occupational Risk, and Clinical Use. J Clin Med. 2021 Mar 22;10(6):1306. doi: 10.3390/ jcm10061306. PMID: 33810063; PMCID: PMC8004846.
15. Van Gerven E, Vander Elst T, Vandenbroeck S, et al. Increased Risk of Burnout for Physicians and Nurses Involved in a Patient Safety Incident. Med Care. 2016;54(10):937-943. October 10, 2016.
16. Waterson J. Making smart pumps smarter, making IV therapy safer. Br J Nurs 2013 Jul;22(Sup13):22-27.
17 . Wang YC, Tsan CY, Chen MC. Implementation of an Automated Dispensing Cabinet System and Its Impact on Drug Administration: Longitudinal Study. JMIR Form Res. 2021 Sep 17;5(9):e24542.
18. Castro Lopes, S., Guerra-Arias, M., Buchan, J. et al. A rapid review of the rate of attrition from the health workforce. Hum Resour Health 15, 21 (2017). https://doi.org/10.1186/s12960017 0195-2
19. Slawomirski L, Auraaen A, Klazinga N. Organisation for Economic Co-operation and Development: Paris, France; 2017. whttps://www.oecd.org/health/health-systems/The-economics-ofpatient-safety-March-2017.pdf
20. Manrique-Rodríguez S, Sánchez-Galindo A, López-Herce J, Calleja-Hernández MÁ, Martínez-Martínez F, Iglesias-Peinado I, Carrillo-Álvarez A, Sanjurjo-Sáez M, Fernández-Llamazares C. Implementing Smart Pump technology in a pediatric intensive care unit: a cost-effective approach. Int J Med Inform. 2014 Feb;83(2):99-105.
21. Campion, Nicole & Thiel, Cassandra & Woods, Noe & Swanzy, Leah & Landis, Amy & Bilec, Melissa. (2015). Sustainable Healthcare and Environmental Life-Cycle Impacts of Disposable Supplies: A Focus on Disposable Custom Packs. Journal of Cleaner Production. 94. 10.1016/j.jclepro.2015.01.076.
22. Lim, S., Gangoli, G., Adams, E., Hyde, R., Broder, M. S., Chang, E., Reddy, S. R., Tarbox, M. H., Bentley, T., Ovington, L., & Danker, W. Increased clinical and economic burden associated with peripheral intravenous catheter-related complications: analysis of a US hospital discharge database. Inquiry: a journal of medical care organization, provision and financing. 2019:56, 46958019875562.
23. Kia A, Waterson J, Bargary N, Rolt S, Burke K, Robertson J, Garcia S, Benavoli A, Bergström D. Retrospective review of determinants of intravenous infusion longevity and infusion failure via a nonlinear model analysis of smart pump event logs. JMIR AI. Submitted May 2023. https://preprints.jmir.org/preprint/48628 (Pre-print, June 2023)
24. Zeana C, Palmieri FE, Gupta V, Ye G, Lao P, Yu K, Kang KS, Schiller L, Purswani M. Association between fluoroquinolone utilization rates and susceptibilities of gram-negative bacilli: Results from an 8-year intervention by an antibiotic stewardship program in an inner-city United States hospital. Sci Prog. 2021 Apr-Jun;104(2):368504211011876. doi: 10.1177/00368504211011876. PMID: 33908291.
25. Dunne MW, Aronin SI, Yu KC, Watts JA, Gupta V. A multicenter analysis of trends in resistance in urinary Enterobacterales isolates from ambulatory patients in the United States: 20112020. BMC Infect Dis. 2022 Feb 28;22(1):194. doi: 10.1186/s12879-022-07167-y. PMID: 35227203; PMCID: PMC8883240
claims or features of
available
ARTICLES 57
Healing Hearts and Empowering Minds: Mental Wellness and Rehabilitation Centers in Alleviating the Global Mental Disease Burden
By Dr. Prem Jagyasi; a global leader in medical tourism and wellness consultancy
The world is facing killing stress. The 2022 report of the Mental Health Million Project based on surveys of over 220,000 people in 34 countries, shows a decline in mental health among all age groups and gender.
Nearly 280 million of the global population have depression. The WHO ranked MDD (Major Depressive Disorder) as the third leading cause of global disease burden in 2008, slated to rank 1st by 2030 (NIH).
Loneliness is a growing killer disease affecting all age groups regardless of sex and color, and it is as dangerous as smoking 15 cigarettes a day. Substance abuse is directly or indirectly responsible for 11.8 million deaths every year.
Mental health problems are the biggest cause of disabilities in the world stemming from depression, anxiety, dementia, and substance abuse. It is costly too! The global economy incurs a $1 trillion loss annually due to lost productivity from anxiety and depression.
Individuals’ mental well-being can no longer be on the back burner. There is a dire need for dedicated spaces that offer treatment, support,
solace, and rehabilitation. Mental wellness and rehab centers are the “havens of hope” for individuals struggling with mental well-being.
The world has acknowledged the significance of mental wellness and rehab centers in healing and empowering lives.

Understanding the Need for Mental Wellness and Rehab Centers
The world desperately needs respite from mental health conditions. Human minds are easy prey to several factors that add to mental woes. Overexposure to technology has snatched mental peace and people are craving for a secured space. Dwindling interpersonal connections and growing economic disparities have thrown everybody into uncontrolled mental misery.
Mental issues snatch 20% of healthy days of an individual’s lifespan. And the saddest part - Only 10% of individuals needing attention or treatment for mental issues receive it.
Mental wellness and rehabilitation centers have been through a radical shift in treatments and settings that are inspiring, not intimidating. They not only heal minds but also provide pre-
MENTAL HEALTH PROBLEMS ARE THE BIGGEST CAUSE OF DISABILITIES IN THE WORLD STEMMING FROM DEPRESSION, ANXIETY, DEMENTIA, AND SUBSTANCE ABUSE. IT IS COSTLY TOO! THE GLOBAL ECONOMY INCURS A $1 TRILLION LOSS ANNUALLY DUE TO LOST PRODUCTIVITY FROM ANXIETY AND DEPRESSION.
JULY.AUG 2023 ARTICLES 58
Namami Health & Mental Wellness Retreat, Kerala India
ventive approaches to avoid bigger issues in the future. Constructed guidance and interventions from deputed mental wellness and rehabilitation centers can effectively address this mammoth disorder impacting millions of lives.
Why Consider a Mental Wellness and Rehab Center?
Addressing mental health conditions needs a multi-pronged approach. Mental illness can manifest in different forms that are hard to comprehend. What is crushing a person deep inside is not easy to find out. Every 40 seconds, a person in the world is committing suicide.
A single counselor or therapist may not be enough for the treatment, an individual may need therapists from different specialties to address their issues. People are eager to seek help, but it often takes weeks and months to see a therapist for the first time. It may take a few more months for diagnosis and treatment plans to get finalized.
Once the symptoms improve, very few adhere to the treatment plans and drop out midway, which could be dangerous in the long run. If there is a relapse, it could need more rigorous treatment plans, more recovery time, and more expenses.
Mental wellness and rehabilitation centers provide a comprehensive range of services tailormade to specific needs. They take a holistic view of the individual and create a supportive ecosystem by combining therapies, counseling, lifestyle modifications, and other activities allowing individuals to function independently.
The consistent access to on-site professionals, counselors, mentors, and therapists roundthe-clock facilitates faster recovery within a specified timespan. Individuals can be back to track with zero chance of recurrence.
The Role and Services of Mental Wellness and Rehabilitation Centers
Mental hospitals and mental wellness centers are not the same despite a few overlapping features. Mental wellness is more than the absence of mental illness where an individual actively strives to achieve a positive state of mind holistically.
Present-day medical wellness and rehabilitation centers cater to clinically diagnosed mental disorders and support those seeking mental well-being through curated holistic wellness programs by combining modern diagnostics, clinical practices, and traditional wellness programs to create an enjoyable journey to recovery. Their services may include but are not limited to:
• Initial diagnostics
• Treatment plans
• Medications
• Group activities
• Traditional Therapies
• Mind-body programs
• Adventure Therapy
• Moderate to High-Intensity Workouts
• Expressive Therapies
• Medically-assisted Detox Treatments
• Healthy Living and Eating
• Sleep Hygiene
• Recreational activities
A high level of personalization and individualized attention is the core of these centers. They maintain a healthy therapist-to-client ratio and practice evidence-based holistic treatments for mind-body-spirit revival. The centers operate with a team of certified and experienced physicians, therapists, clinicians, and skilled non-medical and paramedical staff that align with the center’s objective and treatment philosophy.
The evolving landscape of mental wellness and rehab centers
Ongoing global crises have reopened the conversation on mental wellness. There is a growing need for end-to-end institutionalized support for mental health conditions. Mental wellness and rehab centers with a home-like ambiance are fast replacing intimidating hospital settings.
Luxury and semi-luxury centers are coming up to cater to different market segments. These centers, apart from offering curated mental rehabilitation programs, allow individuals to flourish in their way through work, study, play, and healthy entertaining activities. Many centers are also equipped to accommodate family and
MENTAL HOSPITALS AND MENTAL WELLNESS CENTERS ARE NOT THE SAME DESPITE A FEW OVERLAPPING FEATURES. MENTAL WELLNESS IS MORE THAN THE ABSENCE OF MENTAL ILLNESS WHERE AN INDIVIDUAL ACTIVELY STRIVES TO ACHIEVE A POSITIVE STATE OF MIND HOLISTICALLY.
59 ARTICLES
friends to foster faster recovery of individuals. Individuals get more personalized care and attention without feeling caged, a common feature in traditional rehab centers that often slow recovery.
The feel-at-home ambiance beats fears and evokes positive emotions where individuals can open up easily. They build a keen interest in various aspects of treatments and feel motivated to be on the mental wellness journey. Moreover, these centers are also committed to the continuum of care post-discharge of the individual.
Challenges of Mental Wellness and Rehab Centers
Despite the need, several challenges act as a barrier to its growth.
• The social stigma on mental health conditions has not died out. Rehabilitation centers often find it difficult to attract individuals needing mental health support.
• Resource crunch is a lingering problem with most mental wellness and rehab centers. Barring a few centers that get regular funding from private funding or trusts, many centers find it tough to cover operational costs, hire skilled experts, or innovate therapies.
• The demanding nature of work can make recruiting and hiring skilled staff difficult.
• Maintaining a healthy client-therapist ratio is another big challenge.
• Individuals having mental health conditions may also have other co-occurring disorders that need integrated treatment approaches which might not be feasible in resource-constrained situations.
• Each individual’s rehabilitation needs are unique and can be resource-intensive and time-consuming.
• Many rehabilitation centers lag in continuous program evaluation for improved effectiveness of their treatments.
• Evolving mental health issues and the nature of addiction can be challenging
for mental wellness centers to keep up with the latest practices.
The growing acceptance of the need for mental rehabilitation has changed the perception of mental health conditions. As more people reach out for help for mental issues, mental wellness and rehab centers will evolve with renewed approaches to treatments and settings.
About Dr Prem Jagyasi
Dr Prem Jagyasi, is a global leader in medical tourism and wellness consultancy. An award-winning author and renowned keynote speaker, Dr Prem has travelled to 65+ countries and conducted over 500 workshops and masterclasses. His deep insights have helped medical tourism, healthcare, and wellness businesses scale new heights.

JULY.AUG 2023 ARTICLES 60
More about him at www.drprem.com
THE GROWING ACCEPTANCE OF THE NEED FOR MENTAL REHABILITATION HAS CHANGED THE PERCEPTION OF MENTAL HEALTH CONDITIONS.


"We are blessed to have some of the best medical facilities in Qatar, and I am happy that patients in Qatar have access to the best healthcare that ranks among the best in the world," the Aspetar CEO noted.
Speaking about his recent appointment as the Specialist Consultant at Al Ahli Hospital, Qatar's leading private healthcare organization, the Ireland's Royal College of Surgeons-trained doctor said he saw the move as an opportunity to try new experiences in the private sector.
"I chose Al-Ahli Hospital because I believe it is among the best private hospitals in Qatar, and they have a long history. They have all the specialties. They are a fully functioning hospital that has been in existence for a long time. They have well-equipped neurosurgery, vascular surgery, and cardiac surgery sections, among others. So if I needed the support of all the other specialties, it's there and available. Plus, I have a good team that supports me—a good team of surgeons that supports me. And clearly, this is a very important point. Any surgeon would feel more comfortable having better support whenever he needed it in a hospital. With the facilities available, I could
Dr. Abdulaziz Al Kuwari

CEO of Aspetar Hospital and a Specialist Consultant in Orthopedic and Spinal Surgery at Al-Ahli Hospital
Adopting a healthy lifestyle and maintaining an ideal weight through healthy food and exercise are some of the important steps to prevent common bone problems, Dr. Abdulaziz Al Kuwari, the CEO of Aspetar Hospital and a Specialist Consultant in Orthopedic and Spinal Surgery at Al-Ahli Hospital, said. Speaking in an exclusive interview with "HOSPITALS Magazine", Dr. Al Kuwari identified joint osteoarthritis, herniated discs, fractures in all forms, and back and neck pain as some of the most common orthopedic issues in Qatar, which, according to him, have been witnessing a gradual decline due to the innovative healthcare facilities in the country and the experienced medical personnel in the various hospitals and health centers.
do complex cases, including elderly patients with comorbidities. There seems to be no limit to what we can do. That's why I chose Al Ahli Hospital," he said.
He added that Al-Ahli Hospital offers advanced diagnostic and surgical techniques to treat all spinal problems, with the latest medical equipment and technology such as the 3 Tesla magnetic resonance imaging (MRI) device, microscopic surgical instruments, endoscopes, and high-precision navigation systems that help the medical team diagnose accurately and achieve the best therapeutic results.
Dr. Kuwari said that spinal surgery is one of the most interesting fields where modern advancements and technology have been improving patient outcomes and satisfaction while significantly reducing the rate of complications.
"Nowadays, many old procedures can be performed with minimally invasive techniques, aided by internal scopes and advanced surgical exploration systems, making the work of surgeons easier, more interesting, and faster," he noted.
He warned, however, that surgeons have
AL-AHLI HOSPITAL OFFERS ADVANCED DIAGNOSTIC AND SURGICAL TECHNIQUES TO TREAT ALL SPINAL PROBLEMS, WITH THE LATEST MEDICAL EQUIPMENT AND TECHNOLOGY SUCH AS THE 3 TESLA MAGNETIC RESONANCE IMAGING (MRI) DEVICE, MICROSCOPIC SURGICAL INSTRUMENTS, ENDOSCOPES, AND HIGH-PRECISION NAVIGATION SYSTEMS.
JULY.AUG 2023 62
INTERVIEWS
"Adopting healthy lifestyle recipe for preventing common bone problems."
to be careful when adopting new technology because not every technology is helpful.
"A lot of technologies have developed and suddenly pulled out of the market. So sometimes sticking to the conventional methods that have been there for a long time might be a good option," Dr. Kuwari said.

Highlighting some of his achievements, Dr. Kuwari, who was appointed CEO of Aspetar in 2018 and was one of the youngest at the time, noted that he was the first surgeon to install a magnetic growth rod on a patient in Qatar.
"The patient has scoliosis and a potential growth. You don't want to fuse the spine. You apply something called a magnetic rod where you put screws, and the rod that allows elongation is controlled by a magnetic remote control. And after two or three years, when the patient has finished growing, we do the graduation. Before the graduation, we move to the definitive fixation or fusion."
He added that he has also done a good number of cervical stenosis cases, multiple levels, and posterior cervical instrumentation.
"I was the first one to use the ORM
navigation here in Qatar. I always believed in technology as a way to help, support, and improve the safety and efficacy of the surgery," Dr. Al Kuwari, an avid cyclist who founded the Qatar Cyclists Center, added.
While the seasoned surgeon has handled many cases too numerous to count, the case of a young boy with a congenital deformity that was protruding out through the skin that he handled and who later grew up to become a well-known journalist stands out for him.
"The guy, a Qatari, interviewed me during the FIFA World Cup last year, and it was filled with emotion seeing him healthy, strong, and buoyant. The feeling is simply indescribable when you look back at the health challenges he had back then and what he has become today. I felt fulfilled as a doctor knowing that my training contributed to saving and rescuing a life."
INTERVIEWS
63
A LOT OF TECHNOLOGIES HAVE DEVELOPED AND SUDDENLY PULLED OUT OF THE MARKET. SO SOMETIMES STICKING TO THE CONVENTIONAL METHODS THAT HAVE BEEN THERE FOR A LONG TIME MIGHT BE A GOOD OPTION.
Comprehensive Extremity Reconstructions in Orthopedic Cancers
Comprehensive extremity reconstruction refers to the surgical procedure of rebuilding a damaged extremity, such as an arm, hand, leg, or foot. This type of surgery typically involves the use of advanced techniques and materials to restore both the form and function of the affected extremity.
The procedure of comprehensive extremity reconstruction can be performed for a variety of reasons, including:

• Traumatic injuries: Extremity reconstruction surgery is often performed to repair injuries caused by trauma, such as fractures, dislocations, and soft tissue injuries.
• Tumors: In some cases, tumors or cancerous growths may require the removal of an extremity, which can be re-
constructed using surgical techniques.
• Congenital abnormalities: Some people are born with deformities or abnormalities of the extremities, which can be corrected through reconstructive surgery.
• Degenerative conditions: Certain degenerative conditions, such as osteoarthritis or rheumatoid arthritis, can cause significant damage to the joints and other structures of the extremities, which may require reconstruction surgery to alleviate pain and restore function.
Comprehensive extremity reconstruction surgery typically involves a team of specialists, including orthopedic surgeons, plastic surgeons, and physical therapists. The specific techniques and materials used in the procedure will depend
BONE CANCERS ARE RARER THAN OTHER CANCERS. MALIGNANT TUMORS OF THE BONE ARE DETECTED IN ONLY ONE-TENTH OF THE BENIGN ONES. PROFESSOR LEVENT ERALP, M.D. ONE OF ACIBADEM HOSPITAL'S ORTHOPEDISTS, SAYS THAT FOR EVERY 5000 BREAST CANCERS, ONE SKELETAL SYSTEM CANCER (SARCOMA) IS SEEN.
MEDICAL INSTITUTIONS
JULY.AUG 2023 64
on the individual case, but may include bone grafting, joint replacement, soft tissue reconstruction. Recovery from comprehensive extremity reconstruction surgery can be a lengthy process, requiring extensive rehabilitation and physical therapy to restore range of motion, strength, and function to the affected extremity. However, with proper care and treatment, many people are able to achieve excellent outcomes and a significant improvement in their quality of life.
Diagnosis Process in Orthopedic Cancers
Bone cancers are rarer than other cancers. Malignant tumors of the bone are detected in only one-tenth of the benign ones. Professor Levent ERALP, M.D. one of Acıbadem Hospital's Orthopedists, says that for every 5000 breast cancers, one skeletal system cancer (sarcoma) is seen. Therefore, the experience of pathologists, radiologists and surgeons dealing with the diagnosis and treatment of bone and soft tissue tumors is 5000 times less than that of a pathologist, radiologist and surgeon dealing with breast cancer. In fact, accurate results are obtained when patients with orthopedic cancers are only referred to experienced and educated people. In order to treat these cancers, a correct diagnosis must be made. For the correct diagnosis, it starts with the correct examination and questioning the patient correctly. Prof Eralp, describing the diagnosis process in orthopedic cancers, said, "Since orthopedic cancers are rare, it is

always necessary to suspect the unexpected. We try to obtain clues from the patients to try to reach the correct diagnosis with unthinkable questions." After listening to the patient's story, we try to reveal what this mass is, from the simplest Xray/ultrasound imaging to the most advanced technological MR/PET imaging. Finally, a tissue sample is taken (biopsy) by entering the potential tumoral tissue with a needle, and it is examined by a pathologist who is specialized in this field. We try to reach the correct diagnosis with the sample examined under the microscope. When all these steps are completed, the planning of the patient's treatment begins. If a benign tumor is detected, recovery can be achieved with a correctly performed surgery. If a malignant tumor is detected, chemotherapy and radiotherapy should be added to the treatment before or after surgery, or both.
Correct Surgery is Important in Orthopedic Cancers
The duty of the orthopedist in tumor surgery is to perform the surgery correctly. Correct surgery means removing the tumor from the patient in a way that does not allow the disease to recur. Sometimes, the tumor may need to be removed along with the surrounding capsule or intact tissue. In healthy tissue, sometimes healthy muscles, vessels, nerves, and joints can be found. Whatever is left behind to save the patient's life and limb, it should not be thought of as the patient's limb working as much as possible. Thinking otherwise paves the way for the patient to develop recurrences or metastases in the future. The aim is to remove the tumor from the body with intact borders first. How to bridge or repair the gap formed after the tumor is removed is planned in the second stage. At this stage, plastic surgeons will work with soft tissue transplantation, cardiovascular surgeons with vascular grafts, and orthopedists with mega prostheses or regenerative tissues to create functional (i.e. moving) limbs for the patient.
RECOVERY FROM COMPREHENSIVE EXTREMITY RECONSTRUCTION
SURGERY CAN BE A LENGTHY PROCESS, REQUIRING EXTENSIVE REHABILITATION AND PHYSICAL THERAPY TO RESTORE RANGE OF MOTION, STRENGTH, AND FUNCTION TO THE AFFECTED EXTREMITY. HOWEVER, WITH PROPER CARE AND TREATMENT, MANY PEOPLE ARE ABLE TO ACHIEVE EXCELLENT OUTCOMES AND A SIGNIFICANT IMPROVEMENT IN THEIR QUALITY OF LIFE.
MEDICAL INSTITUTIONS 65
Professor Levent Eralp
These surgical methods are very difficult as they are both long-lasting and require serious planning. At the same time, it should be taken into account that these patients are coming out of heavy chemotherapy and radiotherapy sessions. Since the bodies of these patients are open to many complications, their surgeries should be planned correctly and followed closely. The physician must have one hand on the patient. If the oncoming storm is not noticed, it will destroy everything when it comes.
Orthopedic Oncology is the most difficult branch of orthopedics!
After completing his education as an Orthopedic Specialist at Istanbul University, he received training on total joint prosthesis in Germany, external fixation and Ilizarov in Atlanta, and biological reconstruction in Japan, and still accepts patients in Acıbadem Healthcare Group with the title of Professor. He said that it is the most difficult, most unpredictable branch, the boundaries of which are drawn by scientific studies and open to creativity with past experiences. He said that it is a branch where patient follow-up should be done strictly.
Professor Levent Eralp, who is also an instructor in scuba diving, which he is engaged in as a hobby, said that just like in orthopedic oncology surgery, the rules of scuba diving should be well planned and strictly followed. He stated that if the rules are not set well or not followed, it will be very easy for disasters to occur both during the treatment process of orthopedic cancers and during diving.
Success Brings Happiness
Professor Eralp talked about his patient. They met because of a bone cancer that she was diagnosed with at the age of 8, and mentioned that the patient was operated on by himself after going through an intense chemotherapy period and recovered, and that she continued her life without any problems until the age of 18. He said that at the age of 18, when bone growth was complete, an expected result of the treatment occurred, that is she developed a shortness of 8.5 cm in one leg and she needed to have lengthening surgery. 6 months later
after the operation, she brought her fiancé to meet Dr Eralp. He realized that he had not only saved her life with the first operation, but he understood that she had also been negatively affected socially due to the height difference. The next contact with the patient was established to find out if the pregnancy had a negative effect on the treatment process. When the patient became pregnant, Dr Eralp said that she would have no problems. Finally, seeing his patient with her baby in her arms made him very emotional and he said that he was happy to be the father of the baby’s name.
While most of the patients with tumors in their extremities have their arms or legs amputated, today this rate is done when it is very necessary and it only constitutes 5 percent of the patients. Success in orthopedic oncology is determined by survival rates within 5 years. While this rate was 10-15 percent in the past, it is around 60-65% today.
This success is due to the increase in the experience of orthopedists in limb-sparing surgeries and the increase in the success of the (reconstructive) methods that complete the gaps. Of course, the successful contributions of oncologists in the chemotherapy and radiotherapy treatments of the patient during this treatment process should not be forgotten. Although the experience is less than other types of cancer, we are much more successful in orthopedic cancers than 20 years ago.
Professor Levent Eralp stated that he enjoyed determining the surgical method to treat by making detailed calculations to solve many orthopedic problems. He underlined that they started accepting patients by establishing a unit within the Acıbadem Healthcare Group where only comprehensive extremity reconstruction studies would be done.
You can get free second medical opinion from our physicians, contact us now: https:// acibademinternational.com/
PROFESSOR LEVENT ERALP STATED THAT HE ENJOYED DETERMINING THE SURGICAL METHOD TO TREAT BY MAKING DETAILED CALCULATIONS TO SOLVE MANY ORTHOPEDIC PROBLEMS. HE UNDERLINED THAT THEY STARTED ACCEPTING PATIENTS BY ESTABLISHING A UNIT WITHIN THE ACIBADEM HEALTHCARE GROUP WHERE ONLY COMPREHENSIVE EXTREMITY RECONSTRUCTION STUDIES WOULD BE DONE.
MEDICAL INSTITUTIONS JULY.AUG 2023 66

Ministry of Health
Electronic Health Records
A Digital Revolution for Storing and Managing Medical Information
Patient information, which includes diagnostic tests, reported symptoms, and medical history, is a real goldmine of knowledge that supports early disease diagnosis and better treatment. Doctors check a patient's electronic health record (EHR) before analyzing the relevant data in a medical context. The great majority of hospitals and medical facilities use computerized record-keeping systems nowadays.
Doctors and other healthcare professionals can access a patient's medical file using electronic health records, which help them better plan treatment strategies. This represents a digital revolution in healthcare with the goals of raising patient safety, enhancing care quality, and lowering costs.
Electronic health records are indeed revolutionizing the healthcare sector by offering a digital platform for conveniently storing, managing, and accessing patient medical data as needed. All healthcare professionals who are treating a patient can look over their records, which can help with making recommendations for care.
Your health information is kept in electronic health records and is exchanged between healthcare systems in a safe digital environment. This enables doctors to exchange knowledge and maybe enhance patient treatment. Between hospitals and providers, these exchanges enable the transfer of electronic health information, laboratory test results, and medication lists. Naturally, this lowers undesired copying errors.
Electronic health records are meant to combine patient medical information into a computerized file that is updated in real time and contains information on a patient's medical history, prescriptions, allergies, X-ray pictures, treatment plans, and test results. As a result, there are fewer errors, time is saved, and patients receive better care.
Benefits and Advantages
EHRs allow doctors to precisely and timely monitor the patient's condition, so they can use technology to better care for their patients. Additionally, they provide health analytics that help in recognizing disease patterns, forecasting them, and suggesting potential treatments. In general, these health analytics result in better patient outcomes.
Benefits of Electronic Health Records include:
• Real-time access to accurate, complete, and updated patient information, which increases the efficacy of prescriptions and other recommended medications.
• Quick and simple access to patient information for more effective and coordinated care.
• The capability to safely exchange electronic data with patients and other medical professionals to receive their feedback and obtain a second medical opinion before making the best choice.
• Reducing medical errors and increasing safety by having all illness data and historical information in one file, which aids doctors and other healthcare professionals in making more accurate diagnoses.
• Increasing communication between the patient and the doctor and the quality of that communication. Direct communication between patients and healthcare professionals enables effective management and close supervision of the medical condition.
• Increasing worker productivity and the workflow process within the company by assisting in stress reduction among staff members.
• Managing expenses and lowering costs by decreasing paperwork, enhancing safety, and eliminating redundant testing.
THE PURPOSE OF ELECTRONIC HEALTH RECORDS IS TO INTEGRATE A PATIENT'S MEDICAL DATA INTO A DIGITAL FILE THAT IS CONTINUOUSLY UPDATED AND CONTAINS DETAILS SUCH AS MEDICAL HISTORY, MEDICATIONS, ALLERGIES, RADIOLOGY IMAGES, TREATMENT PLANS, AND LABORATORY RESULTS. THIS CONTRIBUTES TO REDUCING ERROR RATES, SAVING TIME, AND DELIVERING BETTER HEALTHCARE TO PATIENTS.
ARTICLE FEATURES . Electronic Health Records
JULY.AUG 2023 68
Boost in Productivity
Doctors can monitor patient health and access pertinent information by keeping records digitally. As a result, primary caregivers can use electronic health records to boost productivity, allowing them to concentrate on providing high-quality care and enhancing health outcomes.
Better care
In addition to offering preventive treatments, the preservation of data on a patient's health state and medical history has enhanced the management of diseases, particularly chronic ones, leading to better care.
When compared to paper records, the use of such systems in healthcare facilities considerably lowers errors and enhances doctor-patient communication. Instead of a cursory glance during the patient's visit to the clinic, this enables each party to fully access the patient's medical history.
Teamwork Coordination
To improve communication and make the best decision possible for the patient's condition,
all stakeholders working in the healthcare facility have access to the patient's electronic information. Therefore, by boosting the flow of medical information and improving communication between various players in the medical sector, electronic records greatly contribute to improving the quality of healthcare. Healthcare professionals, hospitals, and clinics can access patient medical information more quickly and accurately when using electronic health records.
• Real-time access to accurate, up-to-date, and complete patient data, which improves the effectiveness of prescriptions and other suggested drugs.
• Easy and quick access to patient data for better care coordination and effectiveness.
• The possibility of securely exchanging electronic data with patients and other medical professionals to get their feedback and a second medical opinion before deciding which course of action to take.
• Reducing medical errors and enhancing safety by consolidating all history and disease-related data into a single file that helps physicians and other healthcare professionals diagnose patients more precisely.
ELECTRONIC HEALTH RECORDS CONTRIBUTE TO TRANSFORMING THE HEALTHCARE INDUSTRY BY PROVIDING A DIGITAL PLATFORM FOR STORING, MANAGING, AND QUICKLY ACCESSING PATIENTS' MEDICAL INFORMATION WHEN NEEDED.

Electronic Health Records . ARTICLE FEATURES
69
AI, Art & Neuroscience
By Aylin Altuntas; Founder @AA Executive Consulting, Board Member @Future Conferences

Thou doth make the landscape bright, But also doth hinder sight
Yet despite thy bitter cold, Thou art a thing of beauty
Thy snow-covered trees do unfold, A wonder for all to see....'
Who would ever think AI would enter the world of art and literature? Chatbox about it: "Chat GPT is a program where users can type in a question or a task, and the software will come up with a response designed to mimic a human. It was trained using billions of examples of text across the Internet. One of the key features that sets it apart is that it can understand and generate natural language. This means that it can provide natural and conversational responses, making it a valuable tool for a wide range of applications."
Technology continues to speed up, although sector leaders advise slowing down since humans cannot keep up with the pace. Recently Elon Musk's brain-chip firm received approval from FDA to conduct its first tests on humans. Musk aims to treat Alzheimer's and dementia, and spinal cord diseases and claims that visually disabled people will be able to see.
Denmark's Prime Minister gave a speech at the Parliament prepared by ChatGPT last month. You may ask your chatbox to write you a poem about winter in the style of Shakespeare and the result is:
'.....
Thou bringeth short days and long nights, And blankets the earth and white
ChatGPT is an artificially intelligent chat robot that understands human language and forms human-like texts. Designers, storytellers, translators, researchers, or any other professional related to creativity have already started using it. You may ask AI to write you a poem, a novel, a letter, a column, or an academic paper and ask it to translate it. ChatGPT has read all of Wikipedia and, from beginning to end, what exists on the Internet until 2021. There is a language model with 175 billion probability and parametric statistics, which enables to process billions of words in one second... Ups, it may have raised the bar for us all!"
Although problems such as plagiarism, academic theft, and the poorness of legislation related to data collecting and use have not been adequately solved, the usage of AI apps is rapidly increasing, with Technology Companies dominating all other sectors. (Is it because the USA is the primary exporter of AI?)
CHATGPT IS AN ARTIFICIALLY INTELLIGENT CHAT ROBOT THAT UNDERSTANDS HUMAN LANGUAGE AND FORMS HUMAN-LIKE TEXTS. DESIGNERS, STORYTELLERS, TRANSLATORS, RESEARCHERS, OR ANY OTHER PROFESSIONAL RELATED TO CREATIVITY HAVE ALREADY STARTED USING IT. YOU MAY ASK AI TO WRITE YOU A POEM, A NOVEL, A LETTER, A COLUMN, OR AN ACADEMIC PAPER AND ASK IT TO TRANSLATE IT. CHATGPT HAS READ ALL OF WIKIPEDIA AND, FROM BEGINNING TO END, WHAT EXISTS ON THE INTERNET UNTIL 2021.
JULY.AUG 2023 70 ARTICLES
On the people's side, there is a leap in understanding how the human brain works under the latest developments in neuroscience. For Business Management, the more we learn about the brain, the more we favor developing Emotional Intelligence. A higher EQ with better self-consciousness and empathy leads to balanced decision-making and a more peaceful life. Art, not necessarily being an artist, is a way to develop Emotional Intelligence, which I also use as a tool in my coaching sessions with Managers and Senior Executives. By forming a unique training program for business people in The Wall Art Gallery in İstanbul this year, I am trying to embed art into my Managerial Skills Training to increase agility, emotional resilience, creativity, motivation, stress management and change adaptability.
Neuroscience News published a new study by Turku University from Finland investigating how visual art affects our emotions. The findings reveal how the aesthetic experience can impact the body's emotional response. The research subjects viewed different artworks and described the feelings the art stimulated in their bodies.
The researchers recorded the subjects' eye movements while they viewed the art. In addition, the subjects assessed what kind of emotions each piece of art evoked. Viewing the art evoked many different kinds of feelings and emotions in people. Even though many of the pieces handled sad or scary topics, the emotions that the people experienced were mainly positive.
"The bodily sensations evoked by art also contributed to the emotions: the stronger the body's reaction was to the artwork, the stronger were the emotions experienced by the subject," says Professor Lauri Nummenmaa from the Turku PET Centre at the University of Turku.
"The human emotions presented in art pieces can be absorbed by the viewer unnoticed, through so-called mirroring," says Academician Riitta Hari from Aalto University.
Altogether 1,186 people from different countries participated in the study and they assessed the emotions evoked by over 300 art-
works. The research was conducted with online surveys and eye movement recordings in the laboratory.
The results suggest that our bodies significantly affect the aesthetic experience. Bodily sensations can draw people to art: art evokes feelings in the body, and such stimulation of the body's pleasure centers feels pleasant to the viewer. "This is why the emotions and bodily sensations evoked by art can be used, for example, in mental health rehabilitation and care," Professor Nummenmaa recounts.
info@aaexecutiveconsulting.com
References:
1. 'Can the New AI tool ChatGPT Replace Human Work?, Nisha Patel, CBC News

2.'Chat GPT' Emel Mizrahi, Şalom Magazine, March 2023
3. www.neurosciencenews.com, 'Art Evokes Feelings in the Body', Turku University
NEUROSCIENCE NEWS PUBLISHED A NEW STUDY BY TURKU UNIVERSITY FROM FINLAND INVESTIGATING HOW VISUAL ART AFFECTS OUR EMOTIONS.
71 ARTICLES
Patients with diabetes insulin-free for years after islet transplantation

Many people with type 1 diabetes live in fear of their blood sugar levels suddenly getting too low. If untreated, this hypoglycemia can cause confusion, loss of consciousness and even death.
While most diabetics can control their glucose levels with insulin, some are considered “brittle” – their glucose levels can swing wildly, often dropping without the usual warning signs of shakiness or sweating. Ten years ago, Mark Morrison, who has had diabetes since he was 16, couldn’t feel his lows coming on. Hypoglycemia caused him to crash his car twice. In one accident, he hit a tree and broke his sternum. In the other crash, his car caught fire.
“I could eat the same food, have the same amount of activity, and take the same insulin each day, and one day I would have high blood sugar, and then another day I would have low blood sugar,” said Morrison, who is now 64.
Mallory Kon, diagnosed with diabetes when she was 5, found that as an adult, her blood sugar would go from normal to dangerously low within an hour. Sometimes, her glucose levels would get so low that she would fall asleep
without realizing it. “I was not feeling my lows anymore,” she said, “which was really scary.”
Today, Morrison has been off insulin for 9 years after enrolling in a clinical trial at the University of Chicago Medicine to receive an innovative procedure: an islet transplant. Islets, clusters of cells in the pancreas, contain several types of cells, including beta cells that produce insulin. In type 1 diabetes, a person’s own immune system destroys those beta cells, causing diabetics to need daily insulin to control their glucose levels. An islet transplant transfers donor islets into a diabetic patient’s body. Through the procedure, surgeons infuse donor islets via a small catheter into a patient’s liver without the need for surgery. The beta cells within the islets then begin to produce insulin, and act as a pancreas. Currently, as with any organ transplants, patients still must take anti-rejection medications after the procedure.
Morrison had the transplant in November 2013, and just three weeks later, he was completely off insulin. “I could have Thanksgiving dinner and not worry about how much insulin I needed, and I’ve been off insulin ever since,” he said. “It has been such a blessing for me. I feel so fortunate this happened.”
TEN YEARS AGO, MARK MORRISON, WHO HAS HAD DIABETES SINCE HE WAS 16, COULDN’T FEEL HIS LOWS COMING ON. HYPOGLYCEMIA CAUSED HIM TO CRASH HIS CAR TWICE. IN ONE ACCIDENT, HE HIT A TREE AND BROKE HIS STERNUM. IN THE OTHER CRASH, HIS CAR CAUGHT FIRE.
MEDICAL INSTITUTIONS
JULY.AUG 2023 72
From left, Piotr Bachul, MD, Islet Cell Transplant Research Fellow; Laurencia Perea, BSN, RN; Lindsay Basto, MSN, RN; islet transplant recipient Mark Morrison; visiting physician Michal Komorniczak, MD, and Piotr Witkowski, MD, PhD, Director, Pancreatic
Most Active Center Offering Islet Transplants
Since 2005, surgeons at UChicago Medicine, led by transplant surgeon Piotr Witkowski, MD, have performed 79 islet transplants— including 11 transplants this year. This makes UChicago the most active islet transplant center of the three currently offering the procedure in the U.S. “The high cost covered only by research funding limits the number of transplants and patient access to this leading-edge therapy,” Witkowski said.
“These patients often live in constant fear of dying,” Witkowski added. “This procedure is less invasive than a pancreas transplant and could potentially help hundreds of the most desperate, out of over 1.5 million patients with type 1 diabetes in the U.S.”
Though the procedure has been approved in several countries in Europe as well as in Canada and Australia, it is still considered experimental in the United States. In contrast to other countries, the FDA classifies islets as a biologic drug, not as a tissue or organ for transplant, and has not given islet transplantation full approval.
Witkowski performs the procedure in clinical trials and continues to work on getting approval so any patient who is eligible could receive the therapy. He recently published a perspectives article in the journal Frontiers in Endocrinology arguing for the inclusion of islets into the existing regulatory framework of organs for transplantation.
“Although over the last 20 years islet transplantation has been proven to be safe and effective, it is very unfortunate that current regulations still prevent islets from being available and reimbursed for Americans with diabetes,” Witkowski said. “We need this as the standard of care.”
Continuing to Improve the Procedure
After receiving donor islets in 2014, Kon was off insulin within months. She felt weak for six months after the procedure and craved fatty foods, but that paled in comparison to her previous life of worrying about her glucose levels as she traveled half the year for work.
“I used to have to carry an emergency can of Coca-Cola in my purse, and now I can just go out and not have to worry about my blood
sugar falling low or carrying insulin,” said Kon, who is now 35. “I volunteer for more projects at work because I know I don’t have to worry about my blood sugar while in a meeting or traveling around the country.”
Morrison found he was able to double the miles he could run shortly after the transplant, eventually running a half marathon. He also found that the nerve pain in his hands and feet – a side effect of diabetes – stopped progressing. In his job delivering auto parts, he no longer has to worry about car accidents due to hypoglycemia.
“I know I’ll be able to keep my feet, and my life expectancy has gone up dramatically,” he said. “My blood sugar is now always controlled. In fact, it’s better than most people’s.”
Morrison, Kon and another patient gathered last fall to celebrate 8 years off insulin and compare notes on their new lives. All still visit Witkowski’s clinic for follow-up, and all keep in touch regularly with islet transplant nurses Lindsay Basto, MS, RN, and Laurencia Perez, BSN, RN. “He’s the smartest man I’ve ever met,” Morrison said.
Witkowski continues to study ways to improve outcomes in islet transplantation, such as giving patients anti-inflammatory medication. His team is now working with a company to test putting islets into a device within a patient’s abdominal wall instead of the liver.
“Both Mallory and Mark are examples of patients who have benefited from our advances in islet transplantation therapy, enjoying long-term diabetes-free life after only a single islet infusion and practically without side effects related to immunosuppression,” Witkowski said. “Their kidney, heart and other organ functions, as well as diabetic retinopathy and neuropathy, have remained stable or improved over time.
“Islet transplantation has been proven to be safe and effective, and we are continuing to try to improve outcomes through these different avenues,” he said. “The technology is there. Islet transplantation needs be available to many more patients so we can progress the field, enhance the effectiveness and limit side effects. We hope that our call for urgent regulatory updates will be heard and implemented.”
FOR MORE INFORMATION, VISIT WWW.UCHICAGOMEDICINE.ORG/GLOBAL
SINCE 2005, SURGEONS AT UCHICAGO MEDICINE, LED BY TRANSPLANT SURGEON PIOTR WITKOWSKI, MD, HAVE PERFORMED 79 ISLET TRANSPLANTS— INCLUDING 11 TRANSPLANTS THIS YEAR. THIS MAKES UCHICAGO THE MOST ACTIVE ISLET TRANSPLANT CENTER OF THE THREE CURRENTLY OFFERING THE PROCEDURE IN THE U.S. “THE HIGH COST COVERED ONLY BY RESEARCH FUNDING LIMITS THE NUMBER OF TRANSPLANTS AND PATIENT ACCESS TO THIS LEADINGEDGE THERAPY,” WITKOWSKI SAID
73 MEDICAL INSTITUTIONS
From Despair to Joy for New Mother at Acıbadem Türkiye
When she was told that a premature menopause risk might deprive her of her eggs, Emma was devastated. She had a family history of early menopause and physicians had measured her ovarian reserve as very low. Emma was 27 and married for a year. The couple dreamed of having a child in the coming years, but at the time, they needed to make a critical decision; they could either try to conceive naturally, they could immediately apply IVF treatment in London, or Emma's eggs could be collected and frozen for use in the future. Freezing seemed to make sense, but a quick search online revealed that it was an extraordinarily expensive service in the UK.
Egg Freezing at Acıbadem
The couple had been in İstanbul for vacation two years before this unexpected scenario and they had experienced the world-class healthcare services of Acıbadem hospital. During the trip, Emma’s reflux exacerbated, and they applied to Acıbadem Hospital's emergency department. When she was in the Acıbadem hospital, she was deeply impressed in terms of doctors’ expertise, nurses, its modern design, etc. Moreover, the hospital had more affordable prices when compared to the UK. She came to the conclusion that it was possible to receive high-quality medical services with affordable prices at Acıbadem Türkiye. “I called Acıbadem and asked if it was
AS DOCTORS SAID, EMMA ENTERED MENOPAUSE WHEN SHE WAS JUST 30. TWO YEARS LATER IN AUGUST 2022, THEY VISITED ACIBADEM ATAŞEHIR HOSPITAL. EMMA AND HER HUSBAND DECIDED TO MOVE FORWARD WITH IVF AND ATTEMPT TO HAVE A BABY WITH PROFESSOR CEM DEMIREL’S ASSISTANCE.

MEDICAL INSTITUTIONS
JULY.AUG 2023 74
possible to freeze eggs. They informed me very clearly and shared the cost. At Acıbadem, the average cost of having eggs collected and frozen, and medication was almost one-quarter of any IVF clinic in London. Storage costs are also sensible and affordable at Acıbadem. We decided to go for Acıbadem and freeze my eggs there,” says Emma. Eventually, they attended Acıbadem and a reproductive medicine and infertility expert measured Emma’s ovarian reserve. It was very low. She had a family history of early menopause. Physicians immediately suggested collecting her eggs and freezing them. With the couple’s approval, the process was commenced.
Professor Cem Demirel has an extensive experience in reproductive medicine and infertility. He deals with all kinds of infertility problems, and he performs all kinds of assisted reproductive procedures at Acıbadem, ranging from IVF, insemination, ICSI, testicular sperm extraction, to preimplantation genetic diagnosis

with his team. The team carries out about 2000 IVF cycles per year.
“A little bit of hope was all I wanted at that moment,” says Emma. “Professor Cem Demirel assured that it was possible to use these eggs in the future whenever I was willing and ready to have a baby. Of course, I’m aware that strong promises cannot be made at such cases, but that was the positivity I was looking for. We got back to London with high hopes regarding our future,” Emma keeps on.
Becoming a Mother Thanks to Frozen Eggs
As doctors said, Emma entered menopause when she was just 30. Two years later in August 2022, they visited Acıbadem Ataşehir Hospital. Emma and her husband decided to move forward with IVF and attempt to have a baby with Professor Cem Demirel’s assistance. The professor explained that there was a higher chance of successful pregnancy and birth if the frozen eggs were younger. This was good news to Emma. Because she was 32 now, but her eggs were frozen when she was only 27. “Emma came back to me with her husband asked if they could use the eggs that we had frozen years ago? I said this is why we have frozen them,” says Cem Demirel. The IVF team used the frozen eggs and fertilized them with her husband's sperm. The embryo was transferred back into her uterus. After a fortnight, Emma received the call she was waiting for. She was pregnant! After a healthy pregnancy, their lovely girl Allison was born in April 2023.
“We owe Acıbadem hospital so much for the joy she has brought us. Not only did I receive hope and encouragement at Acıbadem, but also sophisticated medical care that paved the ground for a miracle. I am eternally grateful to Prof. Cem Demirel, his team, and all Acıbadem staff. Last but not least, I want to tell younger women to consider freezing their eggs rather than wait. Do it now, don’t wait,” says Emma.
PROFESSOR CEM DEMIREL HAS AN EXTENSIVE EXPERIENCE IN REPRODUCTIVE MEDICINE AND INFERTILITY. HE DEALS WITH ALL KINDS OF INFERTILITY PROBLEMS, AND HE PERFORMS ALL KINDS OF ASSISTED REPRODUCTIVE PROCEDURES AT ACIBADEM, RANGING FROM IVF, INSEMINATION, ICSI, TESTICULAR SPERM EXTRACTION, TO PREIMPLANTATION GENETIC DIAGNOSIS WITH HIS TEAM. THE TEAM CARRIES OUT ABOUT 2000 IVF CYCLES PER YEAR.
MEDICAL INSTITUTIONS 75
Professor Cem Demirel
Achieve a Beautiful Smile with Orthodontics Treatment at Marble Plus Medical Center
What is the Importance of Orthodontic Treatment?
Orthodontic treatment offers numerous benefits beyond just enhancing the appearance of your smile. Here are some key reasons why orthodontics is important:
• Correcting Dental Misalignment: Misaligned teeth can cause difficulties in speaking, chewing, and maintaining proper oral hygiene. Orthodontic treatment can address these issues by aligning the teeth, improving functionality, and facilitating better oral health.
Aconfident smile can have a significant impact on an individual's self-esteem and overall well-being. Orthodontics, a specialized field of dentistry, focuses on diagnosing and treating misaligned teeth and jaws. If you are seeking professional orthodontic care, Marble Plus Medical Center offers comprehensive treatment options to help you achieve a healthy and beautiful smile. In this article, we will explore the benefits of orthodontics and the specialized services provided by Marble Plus Medical Center.
Understanding Orthodontics!
What is orthodontics?
Orthodontics is a branch of dentistry that deals with the correction and alignment of teeth and jaws. It involves the use of various appliances, such as braces, aligners, and retainers, to gradually move teeth into their optimal positions. The ultimate goal of orthodontic treatment is to improve both the functionality and aesthetics of the smile.
• Enhancing Aesthetics: Orthodontics can correct a range of dental issues, including crooked teeth, overcrowding, and gaps between teeth. By achieving proper alignment, orthodontic treatment significantly enhances the aesthetics of your smile, boosting selfconfidence and improving overall facial harmony.

• Improving Oral Health: Straight teeth are easier to clean, reducing the risk of dental problems such as tooth decay, gum disease, and enamel erosion. Orthodontic treatment helps create an optimal bite, which improves the longevity of your natural teeth.
What is the Orthodontic Services at Marble Plus Medical Center?
Marble Medical Center provides a comprehensive range of orthodontic services tailored to meet the unique needs of each patient. As an experienced orthodontist, you can expect the following specialized treatments:
1. Traditional Braces: Marble Plus Medical Center offers traditional metal braces, which are highly effective in correcting various dental misalignments. These braces consist of metal brackets and wires that gradually move the teeth into their desired positions.
2. Self-ligating bracket system: This
MARBLE PLUS MEDICAL CENTER IS DEDICATED TO PROVIDING EXCEPTIONAL ORTHODONTIC CARE IN A PATIENTCENTERED ENVIRONMENT. HERE'S WHY YOU SHOULD CONSIDER MARBLE PLUS MEDICAL CENTER FOR YOUR ORTHODONTIC TREATMENT
INTERVIEW
MEDICAL INSTITUTIONS
JULY.AUG 2023 76
Dr. Ali Barri, Orthodontic Specialist at Marble Plus Medical Center
advanced system offers faster treatment times, reduced discomfort, and fewer appointments compared to traditional braces.




Patients with self-ligating brackets experience improved oral hygiene due to their sleek design, allowing for easier brushing.

With minimal adjustments and maintenance, self-ligating brackets provide a convenient and efficient orthodontic solution for a straighter, healthier smile.
3. Clear Aligners: For patients seeking a discreet orthodontic solution, Marble Medical Center provides clear aligners, such as Invisalign®. These custom-made, removable aligners are virtually invisible and offer more flexibility during treatment. Marble Plus Medical Center is one of the most successful and trusted centers for Invisalign treatments.
4. Functional and removable appliances: These appliances are designed to correct specific orthodontic issues, such as bite problems and jaw discrepancies, by gently guiding the growth and development of the jaws and teeth.
Functional appliances work by harnessing the natural forces of the muscles and the patient's own jaw movements to achieve desired corrections over time.
With the ability to remove the appliance for eating, brushing, and other activities, patients can maintain good oral hygiene and enjoy their favorite foods without restrictions while still benefiting from effective orthodontic treatment.
5. Retainers: Once orthodontic treatment is completed, retainers play a vital role in maintaining the achieved results. Marble Plus Medical Center offers different types of retainers to ensure the long-term stability of your beautiful smile.
6. Orthognathic Surgery: In some cases, orthodontic treatment may require the collaboration of oral and maxillofacial surgeons. Marble Plus Medical Center has a team of skilled professionals who can provide orthognathic surgery to correct jaw discrepancies and enhance facial harmony.
Why Choose Marble Plus Medical Center?
Marble Plus Medical Center is dedicated
to providing exceptional orthodontic care in a patient-centered environment. Here's why you should consider Marble Plus Medical Center for your orthodontic treatment:
Experienced Orthodontists: The center boasts a team of highly skilled orthodontists who have extensive knowledge and expertise in treating various orthodontic conditions.
State-of-the-Art Facilities: Marble Plus Medical Center is equipped with advanced technology and modern facilities to deliver the highest standard of care.
Personalized Treatment Plans: Each patient receives a customized treatment plan tailored to their specific needs, ensuring optimal results.
Compassionate Care: The team at Marble Plus Medical Center is committed to providing compassionate care, ensuring a comfortable and positive orthodontic experience for every patient.
Conclusion
If you are looking to enhance your smile and address dental misalignments, Marble Plus Medical Center offers comprehensive orthodontic treatment options. Through the expertise of their orthodontists and state-ofthe-art facilities, you can achieve a healthy, functional, and beautiful smile. Take the first step towards transforming your dental health and self-confidence by scheduling a consultation at Marble Plus Medical Center today.
MEDICAL INSTITUTIONS
77
lower
lower
Traditional braces Fixed retainer
arch Fixed retainer
arch
Unearthing the Impact of COVID-19 on Children and Youth’s Mental Health
By Dr. Yousif Eisa Mohamed; Pediatrics Department, Associate Specialist at Al-Ahli Hospital - Doha / Qatar

It is also noted that youth without depressive symptoms experienced significantly more depressive symptoms than pre-pandemic era. While youth with previous health problems before the pandemic got much worse, and have exaggerated response.
Not only that, but youth with a positive COVID-19 diagnosis experienced more mental health problems than those with negative diagnosis, 7% vs 3.4%.
Most common mental health issues after COVID-19 infection include:
• Mood liability
• Obsessive Compulsive Disorder ( OCD )
• Anxiety
• ADHD
• Trauma or stress disorders
IT IS NOTED THAT YOUTH WITHOUT DEPRESSIVE SYMPTOMS EXPERIENCED SIGNIFICANTLY MORE DEPRESSIVE SYMPTOMS THAN PRE-PANDEMIC ERA. WHILE YOUTH WITH PREVIOUS HEALTH PROBLEMS BEFORE THE PANDEMIC GOT MUCH WORSE, AND HAVE EXAGGERATED RESPONSE.
Covid-19 has severely impacted people’s lives. Even 2 years after the pandemic, parents are continuously reporting their deep concerns for their children academic development, social development and their physical and mental health. Academic researchers have proved that COVID-19 pandemic has significant influence on children mental health and disease.
In US, proportion of increased mental health-related emergency room (ER) visits during the pandemic appear as follows:
• Children 5-11 years up 24%
• Youth 12-17 years of age up 31%
Globally, during the first year of COVID-19
• 1 in 4 youth experienced clinically significant depression.
• 1 in 5 youth experienced clinically elevated anxiety symptoms.
• Post-covid Syndrome or Long-term COVID can, but rarely, occur in children and can appear with symptoms of common psychiatric diagnoses
Neurological and Psychiatric Symptoms
Post-COVID-19 Infection include:
Loss of taste and smell, headaches, seizures, stroke, encephalopathy, vascular disease, anxiety, depression, fatigue, concentration issues and memory issues.
During COVID-19 Pandemic children missed schools. This resulted in many psycho-social issues such as:
• Lower social-emotional skills attainment
• Academic underachievement
• Issues with online learning including technical problems, unable to get teachers’ support and poor self-motivation.
COVID-19 pandemic period is also associated with prolonged hours of screen time, social media engagement and gaming.
NOT ONLY THAT, BUT YOUTH WITH A POSITIVE COVID-19 DIAGNOSIS EXPERIENCED MORE MENTAL HEALTH PROBLEMS THAN THOSE WITH NEGATIVE DIAGNOSIS, 7% VS 3.4%.
ARTICLES
JULY.AUG 2023 78
A study in Canada found that 12% of adolescents are spending more than 10 hours a day on social media.
Higher TV or social media time has been linked to worsening psychosocial well-being, Conduct Disorder (CD) issues as well as hyperactivity/inattention.
More time spent connecting with friends virtually versus time spent with family or completing school home work was linked with higher depressive symptoms.
Most distressing issues for youth include:
• Not able to see their friends
• Fear that one of family members or friends contract COVID-19 and become very sick and/or die.
• Inability to participate or attend extracurricular and social activities.
• Also adolescents suffer from existential dread and extremely decreased life satisfaction.
Risks of Behavioral Health Disorders:

• Youth with past history of struggles to emotionally regulate
• Living in areas with more disease burden.
• Reduced contact with supportive adult: parents , teachers, coaches.
How to Support Youth and Families :
We need to work with youth and families to implement consistent and predictable routines for school work, sleep, screen use, physical activity and in-person socialization. It is also important to assess and discuss what youth are doing online. We, additionally, need to provide support to parents through therapy referrals, parents coaching, and appropriate educational content.
Interprofessional Strategies:
1. Strategies to improve interprofessional care: Identify team members and understand their roles and responsibilities. Outline clear expectations from each team member
2. Create clear policies and procedures for
interprofessional care
3. Share psycho-educational resources among team members.
4. Self-care
Conclusion:
1. The COVID-19 pandemic influence the mental health through physiological impacts as well as psychosocial changes.
2. There is a mental health crisis among pediatric population
3. Healthcare providers can evaluate risks and protective factors that influence patients so as to improve their mental health and wellbeing
4. Engaging with interprofessional care is likely to enhance treatment of patients and its outcome
References:
https://www.medscape.org/viewarticle/985773_2
79 ARTICLES
What are the principles of accreditation in hospitals?

And what are the anticipated benefits?
The hospital's achievement of an accreditation certificate contributes to highlighting excellence in health services and safe, effective care provided to patients. This environment aids in improving patient safety on one hand, and enhancing the proficiency of the medical team and healthcare providers on the other, ensuring they remain abreast of all new developments in healthcare.
Today, with the enormous investments being made in the health sector, there is increasing demand to improve the quality of service provided in hospitals, in turn raising public expectations on the importance of controlling the quality of hospital services and ways to enhance them. Obtaining an accreditation certificate from a reputable entity is one of the initial steps towards achieving this goal.
Recent studies have proven a solid correlation between hospital accreditation programs and improved health services they provide. Today, hospital accreditation has become a fundamental requirement for all healthcare facilities aspiring to keep up with developments and provide efficiency, quality, and safety in healthcare services for patients.
Accreditation, therefore, is an internationally recognized evaluation process used to assess the healthcare facility and grant it a certificate verifying the efficiency of its operations, with the stipulation that it will be re-evaluated and updated within regular timeframes to ensure continuous quality improvement and enhancement. Every hospital strives to provide an outstanding team of experienced healthcare providers trained to deliver evidence-based necessary medical care, with strict adherence to international treatment protocols. Accreditation helps any hospital or health facility to enhance patient care in a continuous process to improve quality programs in a way that meets, and possibly exceeds, patient expectations.
Self and external evaluation
Hospital accreditation in this era has become an essential part of the continuous development journey, confirming its commitment to patient care, promoting a culture of safety and quality, and striving towards continuous improvement. Even though every facility or hospital has its own set of internal standards and rules for operations, obtaining an accreditation certificate ensures that it meets the characteristics and standards set by a recognized external organization.
Accreditation is regarded as a multi-step process, starting with a self-assessment by the institution, followed by an external assessment by independent experts, in order to reach a final decision based on internationally accepted quality assessment standards. This ensures alignment with scientific advancements in the fields of specifications, standards, conformity assessment, and laboratory accreditation. Once these standards have been met and high levels of excellence in policies and procedures have been achieved, the organization is then granted the prestigious international certification. The required specifications should be clear enough to enable hospitals to understand the objectives of the standards and the evidence needed to demonstrate their compliance. In this context, the accreditation organization can provide guidance in detailed complementary guidelines, such as training courses for staff and healthcare providers focusing on patient safety and continual quality improvement, in addition to addressing dynamic changes in the healthcare environment.
Therefore, quality standards in hospitals and health facilities act as a common language on a local and international level to define quality and establish safety foundations for the service provided. Hospitals set specific standards and constantly work on developing them, showing a commitment to applying the highest
ACCREDITATION, THEREFORE, IS AN INTERNATIONALLY RECOGNIZED EVALUATION PROCESS USED TO ASSESS THE HEALTHCARE FACILITY AND GRANT IT A CERTIFICATE VERIFYING THE EFFICIENCY OF ITS OPERATIONS, WITH THE STIPULATION THAT IT WILL BE RE-EVALUATED AND UPDATED WITHIN REGULAR TIMEFRAMES TO ENSURE CONTINUOUS QUALITY IMPROVEMENT AND ENHANCEMENT.
ARTICLE FEATURES . Accreditation
JULY.AUG 2023 80

81 Accreditation . ARTICLE FEATURES
quality standards in healthcare by all stakeholders within the work environment.
Principles and Standards
Patient safety remains the highest goal that every hospital strives to achieve, through the application of measures and procedures to protect the patient from any medical errors or negative outcomes while receiving necessary healthcare services.
Key principles and standards that health facilities strive to achieve in their journey to obtain accreditation include providing health services at a distinguished level of quality for the satisfaction of patients, continuously improving these services, exceeding their needs, and utilizing human and material resources to reach the desired goal.
To achieve this desired goal, relevant entities have set strict and disciplined specifications and standards for healthcare quality management. These focus on delivering the best healthcare with the ultimate levels of patient safety and satisfaction.
Long-term expectations involve improving patient care and safety by gaining the necessary expertise, improving outcomes, service quality, and identifying and applying ethical principles during patient care.
The accreditation certificate plays a vital role in enhancing patient care, being a continuous process of quality improvement. Today, many specialized accreditation programs are available for hospitals to ensure a high level of quality in their services.
These accreditations also provide tangible evidence of a hospital's commitment to improving the quality of care provided to patients, ensuring a safe environment, and continuously working to minimize any possible risks faced by patients or staff. Healthcare facility accreditation standards have been established based on the principle of continuous improvement to enhance the quality of care.
A group of international experts teach the accreditation programs that must be followed to obtain certification through workshops, training programs, social activities, and more. Then, the work within the hospital environment
across its different departments is tracked, the provided service is evaluated, and efforts to improve quality are examined. Accreditation aids the hospital in enhancing patient care as a continuous process of quality improvement.
According to the World Health Organization, maintaining health and improving the quality of medical services contribute to reducing mortality rates. To achieve this desired goal, healthcare services should be safe, effective, delivered in a timely manner, and efficiently carried out.
The main principles adopted in hospitals include the following
Providing healthcare in a way that minimizes risks, medical errors, and potential harm to patients.
Delivering healthcare services in a timely manner, reducing waiting and delay periods which have negative effects on the patient's health.
Offering healthcare to all patients fairly and without any discrimination, regardless of the patient's social status, gender, ethnicity, geographical location, economic condition, among other characteristics; healthcare should be delivered with the same competence to all patients without exception.
Keeping up with developments and continuously improving the services offered to patients, exceeding their expectations.
Benefits and Advantages
Obtaining an internationally recognized accreditation certificate is a tangible proof of an institution's commitment to improving the quality of care provided to patients, ensuring a safe environment, and continuously working to reduce any potential risks that patients or staff may encounter. The hospital gains the trust of patients and the community in the healthcare they will receive when needed; it becomes evident to them that this hospital is persistently striving to provide the highest quality, most
HOSPITAL ACCREDITATION IN THIS ERA HAS BECOME AN ESSENTIAL PART OF THE CONTINUOUS DEVELOPMENT JOURNEY, CONFIRMING ITS COMMITMENT TO PATIENT CARE, PROMOTING A CULTURE OF SAFETY AND QUALITY, AND STRIVING TOWARDS CONTINUOUS IMPROVEMENT
ARTICLE FEATURES . Accreditation JULY.AUG 2023 82
accurate, and modern medical services as long as it continues to receive accreditation. The community has become well aware of the importance of a hospital achieving international accreditation and the continuous effort it puts in maintaining this accreditation, which reflects through the services offered to patients.
One of the benefits of obtaining an international accreditation certificate also includes improving efficiency and operational processes. Healthcare accreditation can help healthcare facilities undergo strategic transformations, as most standards provide a framework to assist in establishing a better operational system to achieve operational excellence. Reducing medical errors and preventing them from occurring, as preparing for accreditation requires a comprehensive review of how each depart-

ment works with ultimate precision, allowing the identification of fault lines and gaps that are most vulnerable to risk, then working to reinforce them with continuous monitoring to ensure no errors occur. In this way, the hospital benefits from improving the level of medical service during its preparation period to obtain accreditation. One of the most prominent benefits of accreditation is gaining a competitive advantage, as hospitals strive to showcase their best to be the first choice for patients. With the hospital obtaining an internationally recognized accreditation certificate, this opens up prospects for new partnerships to attract external competencies, in addition to striving to provide the latest technologies and medical devices. Policies and procedures change to steer towards the better and higher quality.
PATIENT SAFETY REMAINS THE HIGHEST GOAL THAT EVERY HOSPITAL STRIVES TO ACHIEVE, THROUGH THE APPLICATION OF MEASURES AND PROCEDURES TO PROTECT THE PATIENT FROM ANY MEDICAL ERRORS OR NEGATIVE OUTCOMES WHILE RECEIVING NECESSARY HEALTHCARE SERVICES.
83 Accreditation . ARTICLE FEATURES
Everything You Need To Know About Your Root Canal Treatment
pocket — to develop. When this happens, the damage has spread past the ends of the roots of a tooth and can cause serious harm.
How a Root Canal is Done
This treatment involves cleaning the infected pulp, then removing the damaged nerve tissue to prevent bacteria from multiplying within the chamber. Once complete, the area is sealed to avoid further infection and prevent an abscess from forming. It also preserves the remaining healthy tissue surrounding the affected tooth.
While root canals involve removing the infected nerve, this doesn’t reduce quality of life. The nerves in teeth do not directly impact their health and function; these are only sensory (i.e. detect hot or cold food and drink).
Root canals are smile-saving treatments. Like any dental procedure, a root canal is designed to restore your strong and healthy teeth. A root canal is practically one last stop before a tooth extraction: the last resort when infected or decayed teeth are past other less invasive treatments. Instead, a root canal saves these infected teeth from total decay and extraction, allowing you to keep them and your healthy smile.
Why It’s Called a Root Canal and What It Does
A root canal treatment is recommended for badly decayed or infected teeth, wherein the nerves and pulps have become irritated and inflamed. These occur due to severe tooth decay, repeated dental procedures, large fillings, and cracks or chips in the tooth after trauma to the face. A root canal is required to prevent decay or infection from causing an abscess — a pus-filled
High-tech tools are now used in root canal treatments that make the procedure easier for both patients and dentists. By the virtue of the technological advancement in modern root canal treatment, teeth can now be treated without any invasive surgery. With the latest instruments and state-of-the-art technologies, dentists now have the resources to complete successful root canals in just one painless visit of the patients.
Today, we can locate calcified canals better than before, and we are not just trying to improve our quality of service, but also striving to perform faster. This is particularly important when dealing with endodontic emergencies and anxious patients.
Let’s take a look at some treatments and innovative technologies that are completely changing the way dentists perform the root canal treatment.

CBCT
Come Beam Computed Tomography has emphatically transformed the practice of Endodontists. CBCT imaging allows Endodontists to have a clear and proper diagnosis of the patient. This imaging provides a threedimensional picture of the endodontic region. With clear visualization of the anatomy, shape
THIS TREATMENT INVOLVES CLEANING THE INFECTED PULP, THEN REMOVING THE DAMAGED NERVE TISSUE TO PREVENT BACTERIA FROM MULTIPLYING WITHIN THE CHAMBER. ONCE COMPLETE, THE AREA IS SEALED TO AVOID FURTHER INFECTION AND PREVENT AN ABSCESS FROM FORMING. IT ALSO PRESERVES THE REMAINING HEALTHY TISSUE SURROUNDING THE AFFECTED TOOTH.
INTERVIEW
MEDICAL INSTITUTIONS
JULY.AUG 2023 84
Dr. Wassef Seirafi, Endodontist at Marble Medical Center
and canal location, the Endodontists can develop a more accurate diagnosis and treatment.
Nickel-Titanium Files
Nickel titanium has properties that surpass the conventional stainless steel files. It is a flexible and shape-memory alloy. Rotary nickel titanium files have powered the endodontists to perform in a more efficient and precise manner. Rotary nickel titanium files in comparison to stainless steel hand files make a root canal’s success more consistent. The shape-memory feature helps the files to shape the canal passages better and enter them with more ease. These nickel titanium files have great resistance to cyclic fatigue with various tapers and cross-sectional designs unlike the stainless steel hand files.
Apex Locater
The aim of technologies in medical science has been to make them simpler and predictable. An Apex Locator is an Endodontic solution that uses fully automatic, multi-frequencies measurements to provide unsurpassed accuracy and reliability. It is a root canal measuring instrument which simplifies complex readings accurately.
Irrigation
Files have a significant impact on the infected pulp tissue within a canal. However, the canal anatomy is complex and files may erroneously miss a few microbial sediments. Therefore, the use of biochemical measures is also important along with mechanical instrumentation that includes filing. The combination of these methods is imperative for an effective root canal treatment. Sodium Hypochlorite is the irrigation choice when it comes to root canal treatment. It is the most likely choice because it has anti-microbial properties and dissolves vital and necrotic pulp tissue. You have to use it with a combination of ethylenediamine tetra-acetic acid (EDTA) since it does not have the properties that dissolve inorganic components of the smear-layer.
Microscopes
Endodontists have to operate on
microscopic cells and tissues in the dental pulp. It is like a junction of nerve endings, tissues, and canals. Microscopes allow practitioners to magnify the core of the tooth in order to get a clearer and more enhanced vision of minute details. This helps them study and identify the damaged traces on the root canals, locate infected areas and better understand the endodontic structure. Advanced microscopes have empowered endodontists to be more confident with their diagnosis and treatments.
Root canal treatments are renowned for their extremely high success rates. At 95% success, many teeth restored with a root canal last a lifetime. Most patients resume their routine once the numbness wears off. In the next few days, it’s normal to experience some sensitivity due to tissue inflammation, which can be eased with painkillers
Once a permanent filling is placed, you can chew confidently, knowing that the once-fragile tooth has now been restored to full function. Just remember — a root canal treatment becomes necessary due to severe tooth decay or infection. There’s no substitute for oral hygiene basics: brush and floss regularly, and visit your dentist for check-ups and cleanings to prevent these problems from recurring.

MEDICAL INSTITUTIONS
85
Remarkable Saudi Success In Crowd Medicine
How Did Artificial Intelligence Contribute to Better Health During Hajj?
The Kingdom of Saudi Arabia receives approximately 3 million pilgrims during the Hajj season, and annually hosts around 15 million Umrah pilgrims from 184 countries. This requires advanced skills and techniques to manage crowds safely, prevent infections, and treat any injuries that may result from stampedes, high temperatures, or other factors. The Kingdom takes a leading role in health and safety management for crowds and is globally recognized in this field. The concept of this healthcare sector originated from the seasons of Hajj and Umrah, and for years, artificial intelligence technology has been introduced to enhance service quality during the Hajj season and provide better care for the pilgrims of the Holy Kaaba, given their simultaneous gathering and specific spatial area.

ARTICLE
. KSA
JULY.AUG 2023 86
FEATURES
Crown Medicine
This branch of medicine was established by Saudi physician Dr. Ziad Memish, who obtained his specialization from the University of Ottawa in Canada, as well as fellowships from the American College of Infectious Diseases and the Royal College of Physicians, and an honorary professorship in infectious diseases from the Liverpool School of Tropical Medicine. This extensive academic background granted him the ability to establish the Global Center for Mass Gatherings Medicine (GCMGM) in collaboration with the World Health Organization. To share these scientific experiences in Crowd Medicine, Dr. Memish organized the world's first conferences on mass gatherings medicine in Jeddah, establishing Saudi Arabia as a global reference in Crowd Medicine and managing public assemblies. An electronic disease surveillance system has also been implemented across the Kingdom, the first of its kind in the region.
Today, the GCMGM, established in 2014, is considered a significant milestone in this field. It is one of three global centers specializing in crowd and human assembly management in various domains. The center plays a pioneering role in organizing and hosting the International Conference on Mass Gatherings Medicine, building collaborations with other public assembly organizations and World Health Organization subsidiaries, coordinating policies and procedures, and managing awareness campaigns related to this field.
Smart Technologies for Optimal Safety
In the current Hajj season of 2023, there has been a greater reliance on artificial intelligence technologies through the launch of the Virtual Health Hospital. The Saudi Ministry of Health announced its participation in this year's Hajj season by providing a range of virtual healthcare services remotely, using the latest medical technologies that have proven their efficiency and effectiveness in rapid medical intervention and accurate disease diagnosis. This enables timely and appropriate medical decision making and the provision of therapeutic services to the guests of Allah.
The hospital is equipped with integrated
medical teams supervised by a number of consultants in various specialized fields. It operates 24/7 across six main tracks, including virtual stroke care, virtual critical care, cardiac services, virtual radiology, virtual medical consultations, virtual clinic consultations, and finally, virtual kidney dialysis services.
What stands out this year is that the Hajj season of 2023 marks the first complete return of pilgrims since the COVID-19 pandemic. In the previous season, the number of pilgrims was 899,353, while the Hajj season in 2021 was limited to only 60,000 participants from within the Kingdom. The 2020 season witnessed around 10,000 participants from within Saudi Arabia alone, compared to approximately 2.5 million pilgrims from around the world in 2019.
This prompted the relevant authorities in the Kingdom, especially in the public and private sectors, to prepare for the current season with full readiness, modern technologies, and advanced plans to prevent pilgrims from infections or stampede-related injuries. Particularly, they focused on protecting pilgrims from heat stroke as temperatures reached 48 degrees Celsius during the Hajj period. The Field Services and Affairs Agency introduced "Smart Sanitization Sweepers" as part of its plans to enhance operations this year. These sweepers work manually and electronically through their dedicated smart application, equipped with artificial intelligence mapping technology. Additionally, the General Authority of Roads announced the use of drones to inspect and evaluate the road network in the holy sites for the first time in this year's Hajj season. This initiative aims to ensure the safety and quality of roads leading to the holy sites. The thermal technology used by these drones allows for observations and automated, rapid, and accurate examination of bridges and ferries.
Saudi Arabia has also innovated new and creative tools to ensure the safety of crowds. The "Jeddah Tool" was developed to enhance preparedness, response, and recovery from health emergencies based on the H-EDRM framework. It serves as a risk assessment tool and has proven effective in mitigating disease risks. The "Salem Tool" was
WHAT STANDS OUT THIS YEAR IS THAT THE HAJJ SEASON OF 2023 MARKS THE FIRST COMPLETE RETURN OF PILGRIMS SINCE THE COVID-19 PANDEMIC. IN THE PREVIOUS SEASON, THE NUMBER OF PILGRIMS WAS 899,353, WHILE THE HAJJ SEASON IN 2021 WAS LIMITED TO ONLY 60,000 PARTICIPANTS FROM WITHIN THE KINGDOM. THE 2020 SEASON WITNESSED AROUND 10,000 PARTICIPANTS FROM WITHIN SAUDI ARABIA ALONE, COMPARED TO APPROXIMATELY 2.5 MILLION PILGRIMS FROM AROUND THE WORLD IN 2019
KSA Crowd Medicine . ARTICLE FEATURES
87
introduced in March 2020 during the peak of the COVID-19 pandemic. It assesses health risks in gatherings and public places and provides recommendations to enhance health safety and prevent virus spread. The "Salem Tool" evaluates 17 factors that could pose health risks. Based on the evaluation, events are classified as high, medium, or low-risk. Decisionmakers and planners receive recommendations based on this classification to ensure effective implementation.
Based on these technologies and others, Saudi Arabia has demonstrated great proficiency in Crowd Medicine, which has been exemplified in the current season through the optimal use of artificial intelligence. This has greatly contributed to monitoring and organizing the movement of crowds, effectively protecting the masses' health, and facilitating the description and provision of necessary treatment in case of health conditions requiring medical attention and follow-up.
Successful efforts and global acclaim
The Saudi Ministry of Health continued its warnings to the pilgrims of the Holy Kaaba, urging them not to abandon the use of sunshades throughout the day, to drink sufficient amounts of water and fluids, to avoid excessive physical exertion without necessity, and to avoid standing for long periods in queues, to prevent the risk of heat stress and heat stroke.
Saudi Minister of Health, Fahd bin
Abdulrahman Al-Jalajel, also announced the success of the health plans for the Hajj season of the year 1444 AH (2023), emphasizing that there have been no outbreaks or threats to public health. From the Command and Control Center in Mina, he stated, "Thanks to Allah and with the great support of the Custodian of the Two Holy Mosques and the follow-up of the Crown Prince, Chairman of the Council of Ministers, I am pleased to announce the success of this year's health plans for Hajj, along with the return of pilgrim numbers to pre-pandemic levels."
He added, "Based on the commitment of the Custodian of the Two Holy Mosques to prioritizing human health, the healthcare
system has prepared over 354 healthcare facilities across all sectors to provide services to the guests of Allah. More than 36,000 healthcare professionals from various sectors have contributed to delivering these services, supported by over 7,600 volunteers."
He revealed that the number of pilgrims who received healthcare services exceeded 400,000, including over 50 openheart surgeries, more than 800 cardiac catheterizations, and over 1,600 dialysis sessions. Virtual services were also provided through the Virtual Health Hospital to over 4,000 pilgrims, and more than 8,000 cases related to sunburn and high temperatures were handled. The proactive awareness efforts played a role in reducing the increase in the number of cases.
Due to the successful organization and satisfactory results, the World Health Organization praised the efforts of the Kingdom of Saudi Arabia during this year's Hajj season, noting that no incidents or disease outbreaks were reported. The organization commended the exceptional efforts made by the Saudi authorities in providing healthcare services to millions of pilgrims and their continuous collaboration with the organization to enhance various areas of healthcare work.
Dr. Ahmed Al-Mandhari, the Regional Director of the World Health Organization for the Eastern Mediterranean, stated, "We appreciate the extraordinary efforts made by the Saudi authorities to organize and provide healthcare services to millions of pilgrims." He affirmed that the organization is confident that the Ministry of Health and all relevant bodies involved in Hajj spare no effort in this regard. The preventive measures ensuring the safety of the pilgrims of the Holy Kaaba were implemented in accordance with the requirements of the International Health Regulations (2005). These measures include effective surveillance to detect any outbreaks of infectious diseases among the pilgrims and promptly respond to them, infection prevention and control, proper sanitation, food safety, vaccination, risk communication, and timely response.
DUE TO THE SUCCESSFUL ORGANIZATION AND SATISFACTORY RESULTS, THE WORLD HEALTH ORGANIZATION PRAISED THE EFFORTS OF THE KINGDOM OF SAUDI ARABIA DURING THIS YEAR'S HAJJ SEASON, NOTING THAT NO INCIDENTS OR DISEASE OUTBREAKS WERE REPORTED. THE ORGANIZATION COMMENDED THE EXCEPTIONAL EFFORTS MADE BY THE SAUDI AUTHORITIES IN PROVIDING HEALTHCARE SERVICES TO MILLIONS OF PILGRIMS AND THEIR CONTINUOUS COLLABORATION WITH THE ORGANIZATION TO ENHANCE VARIOUS AREAS OF HEALTHCARE WORK.
JULY.AUG 2023 88 ARTICLE FEATURES . KSA Crown Medicine

Al-Ahli Hospital saved a 70-year-old female patient from death
By Dr. Atef Ben Yousef; Consultant in Open Heart and Vascular Surgery at Al-Ahli Hospital - Doha / Qatar

Dr. Atef Ben Yousef, a consultant in open heart and vascular surgery, performed a coronary artery bypass grafting procedure on a 71-year-old woman whose life was at risk due to her advanced age and severe stenosis of both her left and right coronary arteries.
The patient suffered from high blood pressure and high cholesterol, which are among the main causes of coronary artery stenosis. This condition occurs when the main blood vessels that supply the heart muscle (the coronary arteries) have difficulty supplying sufficient blood, oxygen, and nutrients to the heart.
According to Dr. Ben Yousef, coronary artery disease often takes several decades to manifest. Symptoms may go unnoticed until a significant blockage occurs and leads to problems or a heart attack. Symptoms of coronary artery disease occur when the heart does not receive enough oxygen-rich blood. If you have coronary artery disease, decreased blood flow to the heart can cause chest pain (angina) and short-
By Dr. Abdulrazzaq Al-Jahani; Head of The Heart Center at Al-Ahli Hospital - Doha / Qatar
ness of breath. Complete blockage of blood flow can cause a heart attack.
Patients should be aware of the signs and symptoms of coronary artery disease, including chest pain (angina). The patient may feel pressure or heaviness in the chest, and some patients report feeling as though someone is standing on their chest. This pain usually occurs in the middle of the chest or on the left side. The pain usually subsides within minutes after the stimulus triggering the condition ceases. In some people, especially women, the pain may be brief or sharp in the neck, arm, or back.
The patient may also experience shortness of breath. The patient may feel as though they cannot catch their breath and may feel fatigued if the heart cannot pump enough blood to meet the body's needs.
Dr. Ben Yousef also notes that blockage of the coronary arteries can lead to a heart attack. Symptoms of a heart attack include the usual feeling of pain or pressure in the chest, as well as pain or discomfort in the jaw, neck, back,
ACCORDING TO DR. BEN YOUSEF, CORONARY ARTERY DISEASE OFTEN TAKES SEVERAL DECADES TO MANIFEST. SYMPTOMS MAY GO UNNOTICED UNTIL A SIGNIFICANT BLOCKAGE OCCURS AND LEADS TO PROBLEMS OR A HEART ATTACK. SYMPTOMS OF CORONARY ARTERY DISEASE OCCUR WHEN THE HEART DOES NOT RECEIVE ENOUGH OXYGENRICH BLOOD. YOU HAVE CORONARY ARTERY DISEASE, DECREASED BLOOD FLOW TO THE HEART CAN CAUSE CHEST PAIN (ANGINA) AND SHORTNESS OF BREATH. COMPLETE BLOCKAGE OF BLOOD FLOW CAN CAUSE A HEART ATTACK.

MEDICAL INSTITUTIONS JULY.AUG 2023 90
stomach, or arms. The patient may also experience shortness of breath, sweating, nausea, vomiting, or lightheadedness. If you or someone you know is experiencing these symptoms, seek medical attention immediately.
Dr. Ben Yousef emphasized the importance for patients to visit their doctor as soon as possible when experiencing any of the mentioned symptoms. He advised adopting healthy lifestyle habits to help maintain the strength and cleanliness of the arteries and prevent the build-up of plaque. To improve heart health, a low-salt and low-fat diet rich in fruits, vegetables, and whole grains, regular exercise, and stress avoidance are recommended.
Dr. Abdulrazzaq Al-Jahani, head of the heart center that performed the diagnostic catheterization for the patient upon her admission to the hospital with chest pain, stated that the images showed severe narrowing in the left main coronary artery and other coronary arteries. This is a serious condition that can be life-threatening if left untreated and is one of the causes of sudden death that we hear about from time to time
in individuals who may not have been diagnosed and treated in a timely manner.

Although stenting and balloon angioplasty are technically feasible in most cases of coronary artery stenosis, the recommendations of international cardiology organizations favor surgical treatment rather than stenting when the stenosis is in the main trunk, as in this case, as long-term outcomes are better in this situation. Therefore, it was agreed to perform the surgical procedure, and the case was explained in detail to the patient and her relatives by Dr. Al-Jahani, the catheterization consultant, Dr. Atef Ben Yousef, the surgical consultant, and Dr. Eman Dawood, the anesthesia consultant.
The procedure went smoothly, and the preand post-operative care was exemplary, resulting in the patient's quick recovery. All respiratory support and other devices were removed in less than 24 hours, and the patient was able to leave the hospital in complete health after all the dangers associated with the serious stenosis in the main coronary artery were eliminated, as mentioned above.
MEDICAL INSTITUTIONS 91
DR. ABDULRAZZAQ AL-JAHANI STATED THAT THE IMAGES SHOWED SEVERE NARROWING IN THE LEFT MAIN CORONARY ARTERY AND OTHER CORONARY ARTERIES.

ARTICLE FEATURES . Medical Laboratory Accreditation Certificates JULY.AUG 2023 92
Medical Laboratory Accreditation Certificates
International recognition of competence, accuracy, and reliability in performance
When a medical laboratory acquires an international accreditation certificate, it is acknowledged for its performance quality, expertise, and dependability. This award is given for satisfying all needed standards and demonstrating a complete commitment to applying the highest quality standards in all services provided. This step is highly regarded by patients, who see it as a reliable indicator of technical competence from the time the sample is collected until the results are issued. Furthermore, this procedure provides clinicians with sufficient and trustworthy information regarding the patient's medical condition, laying the groundwork for a correct diagnosis.
The safety and effectiveness of the devices in terms of accuracy and speed of sample analysis and result display are ensured after an in-depth assessment of standards, specifications, and work mechanisms, after passing through several stages beginning with receiving, registering, dating, and storing samples, moving on to the laboratory workers and the caliber of their certificates, besides to having contemporary systems for classifying and storing data, making sure that these systems are operated by qualified personnel, and adhering to other strict requirements, all of these factors can help laboratories earn international certification.
By adhering to rigid criteria for quality management designed to guarantee accurate medical examination results, a medical laboratory has demonstrated its competence and eligibility to conduct testing operations, earning the accreditation certificate that builds trust and certainty. Additionally, this stage verifies that the laboratory remains current with advancements in the fields of standards, measurements, conformity evaluation, and laboratory accreditation.
Medical laboratories have begun to pay careful consideration to international accreditation certificates as a useful tool for quality assessment, starting with their use of these
specifications as the foundation for their work during the assessment stage, where frequent field audits are carried out to ensure adherence to standards. International standards and norms are now well-aligned with laboratory accreditation for both accreditation bodies and entities that receive accreditation.
The laboratory managers devote their daily efforts to delivering top-notch medical services using the newest technology and equipment under the direction of qualified professionals who hold top-tier accreditations from pioneers in this industry.
Numerous international bodies and organizations have established guidelines and requirements that medical laboratories must follow to obtain an accreditation certificate, proving that they are following global norms for rapid and accurate diagnosis, high productivity, and error-free operation.
The operation of medical laboratories is based on accuracy and reliability, and laboratory results must be as accurate as possible. As a result, to guarantee quality, all operational facets of the laboratory, including organizational structure, operations, and processes, must be directed.
It is crucial to adhere to a strict process for quality control and management in the lab and to keep it up to date. The laboratory is a complicated system with several activities linked to tests and laboratory procedures, as well as numerous people who must accurately carry out the processes and procedures to provide the most precise results and reports with accuracy and dependability. The laboratory examination results are frequently used in hospitals and medical clinics, where doctors completely rely on the accuracy of the examinations and the resulting reports for disease diagnosis and the prescription of appropriate medications. To achieve this, it is imperative to perform all measurement operations and procedures in the laboratory in the best possible way.
MEDICAL LABORATORIES HAVE BEGUN TO PAY CAREFUL CONSIDERATION TO INTERNATIONAL ACCREDITATION CERTIFICATES AS A USEFUL TOOL FOR QUALITY ASSESSMENT, STARTING WITH THEIR USE OF THESE SPECIFICATIONS AS THE FOUNDATION FOR THEIR WORK DURING THE ASSESSMENT STAGE, WHERE FREQUENT FIELD AUDITS ARE CARRIED OUT TO ENSURE ADHERENCE TO STANDARDS.
Medical Laboratory Accreditation Certificates . ARTICLE FEATURES
93
The workflow steps in the laboratory are pre-examination, examination, and post-examination. Each stage has qualities that are equally important to the stage after it. The organization of the examination request, patient preparation, sample collection, transport, storage, processing, and evaluation of samples are all steps in the laboratory examination process as defined by standard specifications. Release of examination results, their authentication, and delivery of the report all involve these stages.
One advantage of a laboratory obtaining globally recognized accreditation is improving the laboratory's reputation and competitive edge, providing more accurate and timely tests and laboratory results, showcasing competency in enhancing work procedures, and earning the trust of clients who are patients and doctors.
Apart from raising the level of cooperation, teamwork, and quality mastery, accreditation certificates for medical laboratories also help to improve efficiency, productivity, and effectiveness in all laboratory operations as well as increase confidence in test results due to increased supervision and control over all operations and activities.
Some requirements for a high-quality laboratory that can receive certificates of international accreditation include being designed in a size appropriate for completing the necessary tasks, providing the necessary protection for laboratory technicians while they work, and providing training on how to use it.

The laboratory must be equipped with a ventilation and lighting system, as well as a self-
alarm and fire extinguishing system that work in accordance with the laboratory's general features, its programs, and the level of hazard present.
To decrease events that individuals may be exposed to by raising their awareness of various hazards, warning and laboratory safety advice instructions must be posted in the laboratory and on its exterior doors, either by hanging signs or panels.
For a laboratory to meet the required standards, it must have a first aid kit on hand to handle any accidents that may arise from exposure to chemicals, electrical shocks, mechanical, physical, or biological risks.
Medical labs that consistently pursue international accreditation certificates must have a set schedule for the routine maintenance of their instruments and equipment, keep records of data and information pertaining to various instruments and equipment, and offer ideal conditions for carrying out laboratory experiments.
To prevent illnesses from spreading to employees and patients who are undergoing medical analyses, safety and preventative requirements must be also provided in laboratories, particularly in the area that deals with blood diseases. The laboratory must be kept spotless, and medical gloves must always be worn, especially while taking patient blood samples. The patient's name, the type of sample, and the required examination that must be performed right away after drawing the sample should then be written on a label that is attached to each sample.
ONE ADVANTAGE OF A LABORATORY OBTAINING GLOBALLY RECOGNIZED ACCREDITATION IS IMPROVING THE LABORATORY'S REPUTATION AND COMPETITIVE EDGE, PROVIDING MORE ACCURATE AND TIMELY TESTS AND LABORATORY RESULTS, SHOWCASING COMPETENCY IN ENHANCING WORK PROCEDURES, AND EARNING THE TRUST OF CLIENTS WHO ARE PATIENTS AND DOCTORS.
ARTICLE FEATURES . Medical Laboratory Accreditation Certificates JULY.AUG 2023 94

Advanced Practices in Quality Management & Patient Safety
The Advanced Practices in Quality Management and Patient Safety is a training program to develop skills and competencies for the health care quality professional. JCI faculty will implement both proven adult learning techniques and student feedback while utilizing digital tools to enhance the participant’s experience.

After completing this 10-week program, you will be able to:
Design a quality program
Manage Data
Reduce risk of harm to patients
Build on accreditation to improve quality
Lead improvement projects
For more information, please visit: www.jointcommissioninternational.org or scan the QR code.

96